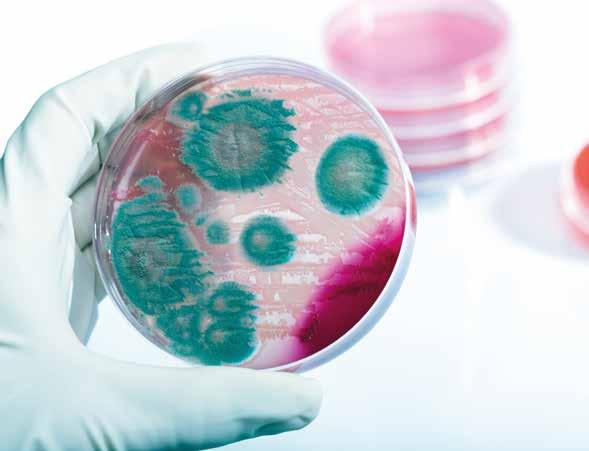

![]()
















iMEAT è un punto di riferimento, confronto e aggiornamento professionale per macellerie, gastronomie, ristorazione e industria di lavorazione carni
TECNOLOGIE, ATTREZZATURE, AROMI, INGREDIENTI per lavorazione, conservazione e cottura
Partecipare con uno stand ti permette di essere protagonista del futuro nel settore carne e presentarti al mercato italiano ed europeo
ECCELLENZE ALIMENTARI per dettaglio e HoReCa
TECNOLOGIE, ATTREZZATURE, TENDENZE, METODI di cottura grill professionale
Posizione strategica all’interno della Food Valley, costi contenuti, giorni ideali scelti per favorire l’affluenza dei visitatori
Attigui all’area GRILL: • PADIGLIONE ESPOSITIVO per dimostrazioni di cottura grill a fiamma libera • AREA ESTERNA per esporre tendenze di cottura bbq


Dip. Biomedicina Comparata e Alimentazione - Università
*Docenti corso di laurea in Sicurezza Alimentare - Università degli Studi di Padova
Negli ultimi anni la riscoperta della frollatura a secco o dry-aging ha fatto conoscere carni con peculiari caratteristiche sensoriali determinate, in modo quasi sartoriale, dal processo attuato da ogni operatore. Tenerezza, succosità e aroma sono conseguenza delle caratteristiche della carne scelta, del processo impiegato, ma soprattutto dell’azione degli enzimi nelle fibre muscolari e dei microrganismi. Come per i salumi, è infatti la combinazione dei fattori suddetti a determinare la particolarità di queste carni che necessitano di un certo tempo per realizzarsi.
La durata del dry-aging dipende dalla scelta del produttore: generalmente 14 giorni sono un tempo
Il rispetto della normativa e il confronto costruttivo con l’autorità competente sono di fondamentale importanza per commercializzare un prodotto sicuro e di elevata qualità, da consumare cotto

I tagli utilizzati saranno inseriti nelle celle di stagionatura, preliminarmente sanificate, solo al raggiungimento delle condizioni ottimali di esercizio
minimo per distinguere la carne dry-aged da quella conservata a basse temperature, mentre 7 giorni non sono sufficienti per sviluppare i caratteri tipici.1,2
Diversamente dalla frollatura a umido o wet-aging, il processo avviene in assenza di confezionamento e quindi in condizioni aerobiche (presenza di ossigeno); questo comporta la perdita di acqua, la diminuzione della disponibilità della stessa (un parametro misurabile detto acqua libera o aw) e la formazione della crosta. Nel contempo sulla superficie esterna vi è la crescita di microrganismi che tollerano l’ossigeno, tra cui diverse specie di muffe, lieviti e batteri, la cui presenza dipende dalla qualità della materia prima, dall’ambiente e dalle attività di lavorazione.
Dopo la rimozione della crosta, le carni sono immesse sul mercato come tali o come preparati a base di carni (es. hamburger), devono quindi rispettare i criteri di igiene e di sicurezza previsti dalla normativa.3
La grande popolarità del dry-aging ha recentemente portato all’inserimento di questo metodo nella normativa alimentare europea4 e, al fine di garantirne la sicurezza, le carni bovine frollate a secco devono rispettare quanto riportato in Tabella 1. Gli operatori del settore alimentare (OSA) possono applicare altre combinazioni di temperatura superficiale, umidità relativa, flusso d’aria e tempo, oppure frollare carni di altre specie, se dimostrano in maniera ritenuta soddisfacente dall’autorità competente che sono fornite garanzie equiva-

Tabella 1 - Parametri stabiliti dal Regolamento delegato (UE) 2024/1141 per le carni frollate in locali o armadi appositi (in vigore dal 9 novembre 2024)
Parametri tecnologici Indicazioni da normativa
Temperatura di conservazione superficiale
Umidità relativa
Flusso d’aria
Tempo
Gestione operativa
Ingresso carni nell’armadio/locale di frollatura
Posizionamento carni in frollatura
Gestione aria
Manutenzione impianto
Rifilatura crosta
Tra –0,5 e 3,0 °C
Massimo 85%
Tra 0,2 e 0,5 m/s.
Per agevolare la riduzione dell’attività dell’acqua (ovvero l’acqua disponibile per la proliferazione microbica e le reazioni degradative) sulla superficie e la formazione della crosta, nella fase iniziale del processo può essere applicato un flusso d’aria più elevato.
Massimo 35 giorni a decorrere dalla fine del periodo di stabilizzazione successivo alla macellazione (e il sezionamento e/o il trasporto dove sarà condotta).
Solo dopo il raggiungimento delle condizioni di temperatura e umidità definite precedentemente.
Appese dall’osso o appoggiate a un ripiano adeguatamente perforato sul quale saranno periodicamente rivoltate in modo igienico.
L’aria che esce dall’evaporatore, rientra nell’evaporatore ed entra in contatto con le carni bovine deve essere filtrata o trattata con raggi UV.
Effettuare una corretta e regolare manutenzione dell’impianto per garantire il corretto funzionamento del sistema di abbattimento della carica microbica dell’aria.
Rifilare la crosta nel rispetto delle norme igieniche per evitare di contaminare superfici e attrezzi.

lenti per quanto riguarda la sicurezza delle carni. Il rispetto della normativa e il confronto costruttivo con l’autorità competente sono di fondamentale importanza per commercializzare un prodotto sicuro e di elevata qualità, da consumare cotto. Vediamo quindi alcuni aspetti importanti.
OPERAZIONI PRELIMINARI
E GESTIONE DEL PROCESSO
Il tempo che intercorre tra la macellazione e l’inizio del dry-aging è molto importante in quanto durante la conservazione può verificarsi la contaminazione delle carcasse con conseguenti problemi dovuti alla presenza di microrganismi. Dovrebbero essere utilizzati tagli primari e secondari il cui pH ottimale è compreso fra 5,5 e 5,7 che saranno inseriti nelle celle di stagionatura, preliminarmente sanificate, solo al raggiungimento delle condizioni ottimali di esercizio
Per ridurre le possibilità di contaminazione microbica i tagli devono essere appesi dall’osso oppure appoggiati su ripiani dal lato della parte grassa o dell’osso, posizionando i tagli più freschi (e quindi gocciolanti) nella parte più
bassa della cella. Inoltre, indipendentemente dalla modalità, dovrebbero essere distanti almeno 3 cm tra loro per permettere la circolazione dell’aria.
Durante la sosta in cella di frollatura, oltre a monitorare i parametri tecnologici, sarebbe opportuno misurare il pH, ricordando che in caso di veloce risalita del pH a valori pari o superiori a 6,0 il prodotto è a rischio alterazione. Infine è fondamentale disporre di un sistema di tracciabilità che, oltre a rispondere a obblighi normativi, è un ottimo approccio per lavorare in qualità.2
ATTENZIONE ALLE MUFFE
E AI BATTERI PATOGENI
Il dry-aging deve essere eseguito a temperature tali da consentire i processi enzimatici necessari per l'intenerimento e lo sviluppo del sapore e dell’aroma, ma sufficientemente basse da inibire la crescita di batteri patogeni (responsabili di malattia) o alteranti, da cui l’indicazione di operare a temperature prossime allo zero.
Durante la frollatura a secco si sviluppano diverse specie di muffe che, attraverso propri en-
Il dry-ageing deve essere eseguito a temperature tali da consentire i processi enzimatici necessari per l'intenerimento e lo sviluppo del sapore e dell’aroma, ma sufficientemente basse da inibire la crescita di batteri patogeni o alteranti
zimi proteolitici, riducono il peso molecolare delle proteine generando così quel substrato di composti responsabili del caratteristico aroma della carne dry-aged. Alcune muffe hanno però la capacità di produrre sostanze note per la loro azione cancerogena, le micotossine. Nonostante le muffe siano in grado di crescere a basse temperature, sembra che la formazione di micotossine non avvenga alle condizioni di temperatura fissate dalla normativa europea. Allo stesso tempo il controllo della catena del freddo, insieme a buone prassi igieniche, consentono di contenere la presenza e di ridurre la crescita della maggior parte dei batteri patogeni, come ad esempio Listeria monocytogenes 1,2 La velocità dell’aria è un parametro verso il quale sembra esservi minore attenzione che però è molto importante. Per favorire la perdita di acqua e migliorare la sicurezza, la velocità dell’aria dovrebbe essere più elevata all’inizio, rendendo forse più complessa la gestione di un processo che vede, in certe realtà, nella stessa cella, tagli con maturazioni diverse. Tuttavia sistemi efficienti, elevati standard igienici e il rispetto delle condizioni indicate in Tabella 1 permettono di ottenere prodotti sicuri e di elevata qualità.2,1
Infine è importante ricordare che dopo la rimozione della crosta, la carne va manipolata e conservata nelle migliori condizioni igieniche e, in assenza di confezionamento sottovuoto o in atmosfera protettiva, consumata entro 5-7 giorni.

Per favorire la perdita di acqua e migliorare la sicurezza, la velocità dell’aria dovrebbe essere più elevata all’inizio
LA CROSTA: MANIPOLARE CON CURA
La crosta ha una carica microbica (numero di microrganismi) più elevata rispetto gli strati sottostanti, è quindi fondamentale porre una grande attenzione a quanto viene in contatto con essa: superfici, attrezzature e mani. Le muffe, purtroppo, hanno una grande capacità di diffondere nell’aria e sulle superfici contaminando ambienti, alimenti e operatori. A tal proposito giova ricordare il ruolo di “untore” svolto dalle mani laddove si alternino operazioni “sporche” (es. rimozione crosta con muffa, attività di cassa) senza procedere con l’igienizzazione delle stesse prima di riprendere la manipolazione di carni e altri alimenti.
Cosa fare della crosta, tutto scarto o possibile impiego? Potrebbe esservi l’ipotesi di un suo utilizzo in preparazioni come hamburger, per conferire un sapore più intenso o, addirittura, consumarla tal quale. In ragione dell’elevata presenza di microrganismi tale pratica è da evitare, a meno che non si utilizzino trattamenti validati in grado di eliminarne la presenza.1 Resta però il fatto che si tratta di una massa che è stata esposta a processi ossidativi e idrolitici e che se poi cotta a elevate temperature, specie se a contatto diretto con la sorgente di calore,

ciò potrebbe comportare lo sviluppo di composti dannosi per la salute.
Il dry-aging della carne è una metodologia di processo relativamente recente i cui effetti sul prodotto finito non sono ancora del tutto chiariti, sia in merito ai fenomeni chimico-fisici sia per quelli microbiologici con particolare riferimento alle loro implicazioni di carattere igienico-sanitario. Particolare attenzione da parte degli OSA va prestata nei confronti dei processi di lunga o lunghissima durata, superiore a quella sopra menzionata, ove diventa rilevante anche le tecnica di cottura del prodotto al fine di contenere la neo-formazione di composti dannosi per il consumatore.
Risulta perciò ancor più rilevante la stretta collaborazione fra OSA e autorità competente per l’analisi delle criticità del processo di lavorazione e l’identificazione delle buone prassi igieniche (temperatura, umidità, velocità dell’aria, durata del processo) necessarie per garantire un prodotto sicuro al consumo.

1. EFSA BIOHAZ Panel (EFSA Panel on Biological Hazards), 2023. Scientific Opinion on the microbiological safety of aged meat. EFSA Journal 2023; 21(1):7745, 101 pp. https://doi.org/10.2903/j.efsa.2023.7745.
2. Savini F, Indio V, Giacometti F, et al. Microbiological safety of dry-aged meat: a critical review of data gaps and research needs to define process hygiene and safety criteria. Ital J Food Saf doi:10.4081/ijfs.2024.12438.
3. Regolamento (CE) n. 2073/2005 della Commis-
sione del 15 novembre 2005 sui criteri microbiologici applicabili ai prodotti alimentari. GU L 338 del 22.12.2005, p. 1–26 e s.m.i.
4. Regolamento delegato (UE) 2024/1141 della Commissione, del 14 dicembre 2023, che modifica gli allegati II e III del regolamento (CE) n. 853/2004 del Parlamento europeo e del Consiglio per quanto riguarda requisiti specifici in materia di igiene per determinate carni, i prodotti della pesca, i prodotti lattiero-caseari e le uova. GU L, 2024/1141, 19.4.2024.
I nostri “Salumi Giulietta” sono prodotti artigianali, lavorati con la voglia di riscoprire la tradizione, fatti in modo naturale e a mano, con tanta passione e attenzione. Per questo si conservano a lungo. Per questo rispettano il sapore della tradizione.

Simone Fracassi è esattamente come lo si racconta: una forza della natura, tanta energia focalizzata sulla sua arte di macellaio e norcino toscano, perché di arte si tratta. Gran maestro della Chianina, Fracassi è la quarta generazione di una famiglia di macellai che opera nel territorio delle Foreste Casentinesi dal 1927, dove il bisnonno Antonio Bruschi apre il primo negozio nel 1927, a fondo valle, nel paese di Rassina (AR). Il nonno materno, Angiolo, in seguito lo porterà su in montagna e aprirà a Chiusi della Verna, sempre Casentino, l’alta valle dell’Arno ricca di boschi che arriva alla provincia di Arezzo. La madre e il padre di Simone impareranno qui i segreti del mestiere, per poi ritornare a Rassina a metà degli anni 70, dove la macelleria prenderà posto tra le botteghe eccellenti della regione. Nel 1982 Simone affiancherà i genitori, fino al 1993, quando andranno in pensione e a lui passerà la conduzione dell’azienda di famiglia. La famiglia – in particolare Simone Fracassi – ha sempre avuto un rapporto stretto con il territorio: lui ricorda che fino agli anni Novanta gli allevamenti della zona erano composti da tante piccole stalle, con meno
Evoluzione nella tradizione: sembra un ossimoro ma è la tattica vincente di Simone Fracassi, che per mantenere viva la cultura del gusto e dei sapori veri senza cedere al pronto-cuoci, ha trovato una sponda ricettiva nella ristorazione consapevole
di 100 capi, da cui si rifornivano per la loro carne, rigorosamente di Chianina, naturalmente. «Questa razza» spiega Fracassi «non è considerata molto remunerativa perché delicata, l’osso e di conseguenza la massa si sviluppano più tardi di altre razze; quindi, per le femmine ci vogliono 16-19 mesi, per i maschi fino a 1922 mesi. Ci vuole pazienza e tanta passione: la Chianina – come la Romagnola, la Piemontese, la Marchigiana, la Podolica – è originaria del suo
territorio, autoctona, e condivide con le altre razze a manto bianco un’interessante peculiarità». Quale? «Se i tempi di crescita e l’alimentazione sono rispettati e corretti, sono tra le razze al mondo che hanno le carni più nutrienti, con un minore tasso di colesterolo e un’alta digeribilità. Molto idonee all’alimentazione umana, quindi, ma bisogna che il macellaio condivida queste tempistiche e sia d’accordo con l’allevatore nel rispettarle».
“La mia filosofia mi porta a pensare che se tratto bene l’allevatore, l’allevatore tratta bene l’animale, il cui sacrificio, alla fine, genera altra vita”

Simone Fracassi è un vero conoscitore e ambasciatore di quella cultura contadina e tradizione dell’eccellenza che non si limita alle parole ma è pura essenza di prodotto
«La Chianina, come la Romagnola e la Marchigiana, è una razza di forza, da lavoro, ma si adatta al pascolo dell’Appennino. Lo sapeva che in questa zona c’è la più alta densità di nascite di bovini? Questo pascolo è ottimo. Io, come il mio nonno prima e il babbo dopo, ci riforniamo da sempre da Vanni Finocchi a Caprese Michelangelo, paese natale del Buonarroti, 650 metri d’altitudine. Una stalla piccola, 50-60 capi tra tori, fattrici e vitelli, con produzione di foraggi e cereali (granturco a parte perché in montagna non cresce) totalmente loro. Una filiera cortissima, gli compro tutte le Chianine. Per queste ragioni, il 100% delle mie carni bovine è di Chianina». Simone Fracassi così descrive questa carne: «Ha una sua tenacia, che richiede masticazione, non scivola via in bocca. Io la frollo quanto basta perché sia pronta - se parliamo di posteriore o di bistecche con osso (come la “fiorentina”) nei maschi, sono 40-50 gg massimo (ma se è pronta a 30, si vende a 30), la femmina dai 1525 gg; se invece parliamo di anteriore, sia va in base alle cotture, dopo 5-6 gg viene messa in vendita».
Chiediamo a Simone cos’è cambiato negli anni nel suo lavoro: «Se guardo alla bottega del nonno e del babbo, che ho vissuto, è cambiato praticamente tutto. Per esempio, i pennuti stanno scomparendo dalla tavola delle famiglie, prima l’anatra, poi la faraona. Io però ho voluto fare una scelta diversa, mantenere una bottega tradizionale: sono pronto a dare alla clientela tutti i consigli necessari su come cucinare ma la mia non è una macelleria-boutique, con i pronti a cuocere, preparati o addirittura già pronti da scaldare. Con il calo del flusso giornaliero in negozio, ho dovuto pensare a un’altra strategia in linea con la mia etica e le mie regole, e mi sono focalizzato sulla ristorazione consapevole. Ho cominciato a fare fiere, dimostrazioni, a confrontarmi con altri: tutto ciò mi ha aiutato a rimanere macellaio».

cuore, milza e diaframma di Chianina al posto delle rigaglie di pollo», prodotto che vende in vasetto. Ultimamente va molto il diaframma. «Vero, ma ce n’è uno per animale, quindi devo metterne via per fare il quantitativo richiesto dal ristoratore. Io devo vendere tutto l’animale, ho quindi con i miei chef un rapporto molto diretto e personale, di forte comunicazione – non importa che comprino tutto da me ma devono sapere che quanto proviene da Fracassi è da Chianina vera, alimentata bene; è frollato bene e tagliato bene». E il negozio di Rassina? «Dopo novant’anni, è una vetrina di 60 mq, un luogo dove gli chef possono venire a trovarmi e da cui andare a visitare gli allevamenti; rimane una bottega di tradizione dove – ce ne sono ancora – un appassionato gourmet fa qualche chilometro per incontrare Fracassi e comprarsi qualche chicca».
«La semplicità della natura. Rimango quello di 60 anni fa, con 40-50 animali macellati all’anno, il mio allevatore gratificato. Rispetto del benessere animale e dei
tempi di crescita. La stessa cosa faccio con il maiale, il Grigio del Casentino, un incrocio allevato allo stato brado nei boschi casentinesi dove si nutre di ghiande e castagne, secondo le regole di un disciplinare rigoroso. Il prosciutto del Casentino è un Presidio Slow Food, ma ne faccio molto poco, perché il resto di questo maiale è difficile da vendere se non stagionato, e la mia struttura è piccola. La carne di un animale che ha pascolato per due anni brado è tenace». Erede di un mestiere tramandato e proseguito con sapienza, senza scorciatoie: il futuro? «In genere? Molto difficile, ci sono grossi problemi nell’appassionarsi all’allevamento e nella lavorazione dell’animale. I piccoli scompariranno. Nel mio caso? È dura più per chi mi sta intorno che per me, che faccio quello che amo e non un lavoro. Cerco di trasmettere a due ragazzi giovani che lavorano con me il mestiere, il mio sapere, la mia filosofia appassionandoli, remunerandoli, dando loro libero dal venerdì pomeriggio alla domenica, come mi chiedono, ma funziona: il lunedì rientrano carichi e riescono a recuperare bene. Difficile quindi, ma io non mollo». Una fortuna è stata incontrare chef come Paolo Teverini, Gualtiero Marchesi, Gaetano Trovato: la vecchia guardia che era attenta al gusto e alle evoluzioni
«Oggi ci sono una settantina di ristoranti che sono clienti Fracassi, tra i quali suddivido i vari tagli, secondo le richieste». Nel rispetto della tradizione toscana, Simone usa l’animale intero, come testimonia il suo Nero di Chianina, di cui è ideatore e depositario: si tratta di un recupero di tutte frattaglie, «Una sorta di pasta per il crostino toscano, realizzata con fegato,





















INGREDIENTI PER 4 PERSONE
• 8 scampi
• 200gr di fragole
Olio, sale e pepe q.b.


SCAMPI E MANZO, DUE ECCELLENZE DELL’ISOLA DI SMERALDO, IN UN UNICO SORPRENDENTE PIATTO
• 400 gr di girello di carne irlandese
Per la salsa (una maionese al whiskey):
• 1 uovo

• 1 cucchiaino di succo di limone
• Un cucchiaio di whiskey irlandese
Un pizzico di sale
• 200 ml circa di olio di arachidi
PROCEDIMENTO


La ricetta della Chef Sara Conforti, membro dell’esclusivo CIBIC, lo Chefs’ Irish Beef Club, unisce in un perfetto connubio i due prodotti di eccellenza di questa terra: gli scampi si fondono con la carne di manzo, avvolti da una particolare maionese al whiskey.






















Togliere il carapace e l'intestino degli scampi, sgrassare completamente la carne e lavare le fragole. A questo punto, fare una battuta a coltello di tutti i nostri ingredienti tenendoli separati, condirli con olio sale ed un pizzico di pepe (le fragole devono essere lasciate in purezza cioè non condite), far riposare in frigo per circa 30 minuti.




Per la maionese unire un uovo intero, il succo del limone, il cucchiaio di whiskey ed il sale, con l'ausilio di un frullatore ad immersione, iniziare a montare il tutto aggiungendo a filo l'olio di arachidi, otterremo una consistenza liscia ma non eccessivamente densa.







In un coppa pasta montiamo la nostra battuta a coltello ponendo in basso il manzo (di circa 1,2 cm), poi gli scampi ed infine le fragole, decorare con delle foglie di menta o di basilico o dei fiori eduli.









La temperatura di servizio consigliata è 6°C; da stappare al momento del servizio.






















È il classico spumante “tutto pasto”. Ideale se servito da aperitivo in abbinamento a salumi, tra cui il tipico salame di Varzi, o la coppa piacentina o la pancetta. Ottimo anche con risotti a base di pesce o di carne. Tra i secondi piatti, trova un buon abbinamento con grigliate e fritture di mare e di terra. Il suo nerbo e la struttura lo rendono ideale per accompagnare un pasto completo, prediligendo i cibi unti e sapidi.
Il Monsupello BRUT ROSE’ ha conseguito il primo Tre Bicchieri nella storia dei vini spumanti rosati sulla Guida Vini d’Italia Gambero Rosso 2010 e titolo di Grande Vino sulla Guida Slow Wine 2011.




L’uvaggio è Pinot nero, prodotto da vigneti di prima fascia collinare nell’Oltrepò pavese nei comuni di Torricella Verzate e Oliva Gessi.






La vinificazione in rosa ha inizio con un breve periodo di stazionamento a freddo e in ambiente inerte delle uve in pressa, per l’estrazione della parte colorante dalle bucce di Pinot Nero. Segue la pressatura soffice dell’uva intera, che porta alla separazione del mosto rosato dalle vinacce; in contenitori diversi si separano il mosto fiore (ovvero il primo 50% di sgrondo liquido di pressatura, più fruttato, acido e fine) dal mosto di seconda pressatura. Il mosto fiore, chiarificato e travasato dopo circa un giorno, viene fatto fermentare in vasche d’acciaio ad una temperatura controllata di 18 °C.




















Dopo un periodo di affinamento in acciaio, viene fatta la cuvè che subisce stabilizzazione proteica e tartarica e una filtrazione; nel “tiraggio” viene messa in bottiglie champagnotte insieme ad una liqueur de tirage, composta da vino, zucchero e lieviti selezionati. Le bottiglie, che vengono tappate con bidule e tappo a corona d’acciaio, vengono accatastate in cantina a rifermentare ad una temperatura costante di 14°C; l’affinamento di post-fermentazione sulle scorze di lievito dura per un periodo che va dai 30 mesi in su.


Dopo il remuage delle bottiglie sulle pupitres, nella fase di degorgement la bottiglia viene stappata à la glace, viene eliminato il residuo dei lieviti di rifermentazione e viene aggiunta la liqueur d’expédition; infine lo spumante viene tappato col sughero a fungo, e preparato per la vendita.






CON GLI ESCLUSIVI SISTEMI AI SILICATI
D’ARGENTO E LAMPADA UVC DI DRY AGER
Il sistema antibatterico è una tecnologia specifica per le celle di maturazione in grado di arrestare i batteri nocivi.
Offri ai tuoi clienti la sicurezza alimentare.
Scopri l’eleganza della nuova linea Black Edition
Approfitta della convenienza del noleg gio operativo


www.tecnologiealimentari.sm


Il commercio globale si è “aperto” alle specie selvatiche e le norme che regolano questo settore sono complesse
Le carni di selvaggina hanno dimostrato negli ultimi anni un costante incremento della domanda e dell’offerta. In particolare, la preparazione di piatti a base di carne di selvaggina nella ristorazione pubblica si ritrova con sempre maggior frequenza anche al di fuori delle aree tradizionalmente interessate. A seguito di questa crescente richiesta, il commercio globale si è “aperto” alle specie selvatiche e le norme che regolano questo settore sono complesse, variano sia tra i diversi gruppi tassonomici cacciati, che all’interno degli stessi (Hughes, 2021). Parallelamente è in atto una notevole crescita demografica di talune popolazioni di animali selvatici poiché la progressiva urbanizzazione della popolazione umana ha consentito il ripristino di aree boschive, habitat ideale per molti animali selvatici (Conferenza Permanente per i Rapporti Tra Lo Stato, Le Regioni e Le Province Autonome Di Trento e Bolzano – Repertorio Atto n. 34/CSR, 2021). Tra le specie animali selvatiche più diffuse nel commercio alimentare c’è il gruppo degli ungulati, non ancora ben definito tassonomicamente. Gli ungulati sono mammiferi che appartengono a due ordini: i Perissodattili e gli Artiodattili. Al primo gruppo tassonomico appartengono specie selvatiche come rinoceronti, cavalli selvatici e tapiri che non sono presenti nel territorio italiano. Il secondo, invece, si

divide in tre sottordini: quello dei Suiformi che comprende anche il cinghiale, quello dei Tilopodi, che comprende i cammelli e i dromedari (non presenti in Italia), e quello dei Ruminanti che si dividono a loro volta in diverse famiglie tra cui quella dei Cervidi (cervo, capriolo e daino) e quella dei Bovidi (stambecco, camoscio e muflone), entrambe presenti sul territorio nazionale. Nonostante l’incremento delle popolazioni avvenuto per gran parte degli ungulati negli ultimi anni prevalentemente nelle zone alpine e nell’Appennino settentrionale, l’attuale distribuzione a livello nazionale non
interessa tutto il territorio ad eccezione del cinghiale che occupa tutto l’areale potenziale (Meneguz P. G., 2019). In particolare, nelle zone centro-meridionali le popolazioni di cervidi rimangono ridotte e frammentate. Il camoscio popola le Alpi e gli Appennini, i caprioli e i cervi i rilievi del Centro e del Nord della penisola, mentre il daino, introdotto dall’uomo, presenta una distribuzione puntiforme, disconnessa e non omogenea nel territorio (Meneguz P. G., 2019).
L’uso della carne di selvaggina come fonte alimentare è attualmente una tendenza in cresci-

ta nel nostro Paese (Giuggioli et al. 2018). Questi prodotti hanno un legame forte e storico con la tradizione culturale e culinaria, ma sono anche apprezzati per le loro caratteristiche sensoriali e nutrizionali. Un importante contributo per la fornitura di questo tipo di prodotto è la caccia. Praticata da sempre per la sopravvivenza, la caccia si è evoluta in un’attività ricreativa con notevoli interessi commerciali e l’incremento nelle aree boschive della taglia delle popolazioni degli ungulati ha inevitabilmente messo in contatto questi ultimi con l’uomo. A causa di questi incontri sempre più frequenti e per i diversi servizi ecosistemici che questi animali offrono all’uomo, è evidente la necessità di attuare il prima possibile delle norme di sicurezza relative alla caccia e al consumo di selvaggina (Giuggioli et al. 2018). La complessità nelle catene di approvvigionamento alimentare, che potrebbe coinvolgere anche il mercato della selvaggina, è emersa chiaramente in occasione della cosiddetta crisi “Horsegate” del 2013,
in cui la carne di manzo è stata adulterata in modo fraudolento con carne di cavallo coinvolgendo addirittura 19 Paesi e provocando l’avvio di indagini e la predisposizione di piani di campionamento ad hoc sia nei mercati al dettaglio che nei servizi di ristorazione nell’Unione Europea (Brooks et al. 2017).
RISCHI DA AGENTI ZOONOTICI
Salmonella spp. e Yersinia enterocolitica
Data l’elevata richiesta di prodotti di selvaggina da parte dei consumatori, la valutazione della loro salubrità, in particolare dei rischi zoonotici legati al loro consumo, assume maggior rilievo. I rischi microbiologici riguardanti gli alimenti derivati da animali selvatici cacciati, possono essere diversi in modo qualitativo e/o quantitativo, rispetto ai rischi associati al consumo di alimenti a base di carne di animali da reddito (IZS VE 05, 2015). La carne di selvaggina cacciata, rispetto alle carni di animali allevati, è spesso lavorata con metodi artigianali basati su proce -



dure tradizionali e non standardizzate. Le informazioni relative a tali procedure, soprattutto per quanto riguarda l’igiene di questi prodotti, risultano scarse. Un classico esempio italiano è la contaminazione delle carcasse di cinghiale (Sus scrofa) da Salmonella spp. e Yersinia enterocolitica. Il cinghiale è una delle specie più comuni di ungulati in Italia (Bonardi et al. 2021) e la loro presenza è stata ben documentata in tutto il territorio con un’alta prevalenza negli Appennini del centro-Italia. Grazie al loro incremento di popolazione il consumo di carne di cinghiale è aumentato proporzionalmente. Come riportato da Bonardi et al. (2021), la ricerca di Salmonella spp. è considerata prioritaria nelle analisi anatomo-patologiche finalizzate a garantire un’alta qualità della carne di cinghiale dal punto di vista sanitario. A conferma di quanto detto, anche il recente Report EFSA relativo al 2020 (“The European Union One Health 2020 Zoonoses Report,” 2021) colloca la salmonellosi e la yersiniosi tra le prime quattro zoonosi più frequentemente rilevate in Europa.
Trichinellosi
Un altro fattore di rischio che può causare zoonosi è senza dubbio la già citata Trichinellosi. Essa è una malattia parassitaria causata da un parassita del genere Trichinella in grado di colonizzare mammiferi, uccelli e rettili. La Trichinella passa dall’animale all’uomo tramite l’ingestione di carne fresca contaminata di alcune specie, come il cinghiale. Il rischio di zoonosi è quindi associato al consumo di carne poco cotta, per esempio gli insaccati freschi o stagionati, che andrebbero consumati solo se provenienti da animali preventivamente controllati dal punto di vista sanitario (Mattiello & Gazzaroli, 2016).
Inoltre, da uno studio di Grassi et al. (2019), è emerso che diverse specie di ungulati tra cui capriolo, cinghiale, cervo, camoscio e muflone, reservoir di malattie trasmesse da zecche
come la meningoencefalite (TBE) e la malattia di Lyme, possono fungere da potenziali vettori nei confronti dell’uomo. Dallo studio si evince che le positività riscontrate nelle zecche comportino un problema emergente soprattutto per il Friuli Venezia Giulia. Si conferma dunque mandatorio prestare molta attenzione per quanto riguarda il commercio delle carni di selvaggina.
ETICHETTATURA E IDENTIFICAZIONE
Data l’insorgenza di un aumento da parte dei consumatori della domanda di carni di animali selvatici cacciati e della presenza dei rischi sanitari annessi, negli ultimi anni è aumentato l’interesse per la genuinità della carne (Ballin N. Z. 2010). Il consumatore è molto più attento alla qualità dei prodotti che consuma e ripone fiducia nelle informazioni riportate in etichetta,
la cui accuratezza è quindi fondamentale per una scelta informata e consapevole da parte del consumatore. Parallelamente all’aumento della domanda, tuttavia, alcuni studi hanno evidenziato un incremento anche delle frodi commerciali che interessano i prodotti a base di carne. Il più delle volte le frodi interessano un’incompatibilità tra il prodotto commercializzato e quanto riportato nell’etichettatura (Kaltenbrunner et al. 2019). Nel dettaglio, spesso accade che la specie indicata sia presente in proporzioni diverse da quelle riportate in etichetta o, ancor più grave, il prodotto commercializzato non sia della specie indicata, ma appartenga ad una specie diversa, magari meno pregiata, commercializzata sotto falsa etichetta (Moreira et al. 2021). Questo pone degli interrogativi anche sul rispetto di tutti i protocolli sanitari per i cibi commercializzati sotto falsa etichetta e di conseguenza apre il problema della tutela del consumatore rispetto anche ad eventuali impatti etico/religiosi che possono interessare il consumo di carne.
Oltre quindi ad effettuare controlli sulla filiera produttiva e stilare normative per il controllo sanitario, negli anni si è reso necessario (almeno a campione per i lotti prodotti) affiancare una caratterizzazione genetica del prodotto commercializzato al fine di verificare la corrispondenza della specie identificata con quanto riportato sull’etichetta. Attualmente, i metodi più utilizzati per gli alimenti sfruttano diverse tipologie di marcatori molecolari per l’identificazione di specie di appartenenza. In particolare per i prodotti a base di carne, il metodo più utilizzato è l’analisi di marcatori mitocondriali quali il DNA barcoding.
Il DNA barcoding
Il DNA barcoding è un metodo che sfrutta l’amplificazione e il sequenziamento di una porzione del gene codificante per la subunità

I della Citocromo Ossidasi utilizzato per l’identificazione di specie della maggior parte delle specie animali (Chen et al. 2015). Il nome si riferisce metaforicamente alla modalità con la quale uno scanner identifica qualsiasi prodotto commerciale attraverso la lettura di un codice a barre che lo identifica in maniera univoca. Analogamente il DNA barcoding si basa sul principio che ogni specie animale possieda un suo codice a barre di DNA. Un ambito in cui l’utilizzo di questo metodo è ormai consolidato è nell’identificazione di specie ittiche. Nel 2005 ha avuto inizio una campagna chiamata “Fish Barcode of Life” (FISH-BOL), un progetto su scala internazionale finalizzato a creare una libreria di sequenze di DNA di riferimento per tutte le specie ittiche. Il metodo analitico predisposto permette l’amplificazione di una regione di circa 648 bp del gene mitocondriale COI. Ad oggi sono state codificate circa 8000 delle 31000 specie di pesci attualmente riconosciute, includendo la maggioranza delle specie più importanti dal punto di vista commerciale (Ward R. D. 2012; Ward et al. 2009). Il vantaggio nell’utilizzo di questi marcatori risiede nelle caratteristiche intrinseche proprie del genoma mitocondriale viste precedentemente.
L’analisi del DNA barcoding prevede l’iniziale estrazione degli acidi nucleici dal tessuto muscolare, l’amplificazione dei tratti di genoma riconosciuti universalmente per l’identificazione di quasi tutte le specie animali e una successiva corsa elettroforetica tramite la quale si verifica l’avvenuta amplificazione. A seguito dell’amplificazione del gene di interesse, nell’analisi del DNA barcoding, si procede con il sequenziamento. Il sequenziamento ad oggi più utilizzato è il metodo Sanger che consente di ottenere la sequenza nucleotidica corrispondente al gene target di singoli campioni per volta. Le sequenze ottenute vengono analizzate interrogando dei database per il confronto

con altre sequenze disponibili di specie note (Kress & Erickson, 2012). In questo contesto, la completezza delle banche dati disponibili ha un ruolo fondamentale per la corretta assegnazione delle sequenze alla specie di appartenenza (Neto et al., 2021). Questo approccio ha riscosso grande successo in molte discipline come la biologia della conservazione, l’ecologia e le scienze forensi (Bhaskar et al. 2020). Come riporta lo studio di Silva et al. (2015), nonostante l’utilità del mtDNA, l’identificazione delle specie dovrebbe essere rafforzata dall’uso complementare di un gene nucleare superando così alcuni limiti dell’uso del genoma mitocondriale tra cui l’impossibilità di identificare individui ibridi o fenomeni di introgressione (trasferimento di genoma mitocondriale tra specie attraverso un ibrido) dal momento che il genoma mitocondriale è in grado di fornire informazioni esclusivamente sulla linea materna. Un chiaro esempio di applicazione del DNA Barcoding è riportato dallo studio realizzato da D’Amato et al. (2013), dove è stata verificata l’autenticità delle etichette commerciali in Sud Africa in prodotti a base di carne nei mercati
locali. La sequenza genetica identificata come target, è stata quella codificante per l’enzima citocromo ossidasi I ed alcune regioni geniche codificanti per il citocromo b. Tale metodo si è rivelato efficace nell’identificazione di specie, ed ha consentito di evidenziare la presenza di carne di specie animali non dichiarate nel 69,2% (101/146) dei prodotti analizzati.
CONCLUSIONI
Il metodo del DNA barcoding si è confermato essere efficace nell’identificazione di specie animali partendo sia da una matrice non lavorata che da una lavorata. Attraverso l’analisi del DNA barcoding, che si avvale della tecnica del sequenziamento Sanger, è possibile sequenziare solamente i prodotti di amplificazione ottenuti da un individuo per volta. Se questi sono tutti uguali si ottiene un cromatogramma leggibile e l’identificazione della specie è univoca, viceversa, la presenza di ampliconi diversi dovuta alla coamplificazione di specie diverse incluse nello stesso prodotto causa la produzione di cromatogrammi con doppi picchi (o a volte illeggibili).
Ballin, N. Z. (2010). Authentication of meat and meat products. Meat Science, 86(3), 577–587. https://doi.org/10.1016/J.MEATSCI.2010.06.001
• Bhaskar, R., Kanaparthi, P., & Sakthivel, R. (2020). DNA barcode approaches to reveal inter-species genetic variation of Indian ungulates. Mitochondrial DNA. Part B, Resources, 5(1), 938–944. https://doi.org/10.1080/23802359.2 020.1719912
Bonardi, S., Tansini, C., Cacchioli, A., Soliani, L., Poli, L., Lamperti, L., Corradi, M., & Gilioli, S. (2021). Enterobacteriaceae and Salmonella contamination of wild boar ( Sus scrofa) carcasses: comparison between different sampling strategies. European Journal of Wildlife Research, 67(5). https://doi.org/10.1007/S10344-02101531-0
Brooks, S., Elliott, C. T., Spence, M., Walsh, C., & Dean, M. (2017). Four years post-horsegate: an update of measures and actions put in place following the horsemeat incident of 2013. NPJ Science of Food, 1(1). https://doi.org/10.1038/ S41538-017-0007-Z
• Chen, J., Jiang, Z., Li, C., Ping, X., Cui, S., Tang, S., Chu, H., & Liu, B. (2015). Identification of ungulates used in a traditional Chinese medicine with DNA barcoding technology. Ecology and Evolution, 5(9), 1818–1825. https://doi.org/10.1002/ ECE3.1457
Conferenza Permanente per i rapporti tra lo Stato, le Regioni e le Province Autonome di Trento e Bolzano - Repertorio atto n. 34/CSR. (n.d.). Retrieved September 16, 2022, from https:// www.statoregioni.it/it/conferenza-stato-regioni/sedute-2021/seduta-del-25032021/atti/ repertorio-atto-n-34csr/
• D’Amato, M. E., Alechine, E., Cloete, K. W., Davison, S., & Corach, D. (2013). Where is the game? Wild meat products authentication in South Africa: a case study. Investigative Genetics, 4(1). https://doi.org/10.1186/2041-2223-4-6
• G., M. P. (2019). Gestione del cervo in Italia: quali prospettive? Uniwersytet Śląski, 65–74. https:// doi.org/10.2/JQUERY.MIN.JS
• Giuggioli, G., Olivastri, A., Pennisi, L., Paludi, D., Ianieri, A., & Vergara, A. (2018). The hygiene-sanitary control in the wild game meats. Italian Journal of Food Safety, 6(4), 222–224. https:// doi.org/10.4081/IJFS.2017.6875
• Hughes, A. C. (2021). Wildlife trade. Current Biology : CB, 31(19), R1218–R1224. https://doi. org/10.1016/J.CUB.2021.08.056 Istituto Zooprofilattico Sperimentale delle Venezie. (n.d.). https://doi.org/10.2903/j.
efsa.2013.3267
• Kaltenbrunner, M., Mayer, W., Kerkhoff, K., Epp, R., Rüggeberg, H., Hochegger, R., & Cichna-Markl, M. (2019). Differentiation between wild boar and domestic pig in food by targeting two gene loci by real-time PCR. Scientific Reports, 9(1). https://doi.org/10.1038/S41598-019-45564-7 Kress, W. J., & Erickson, D. L. (2012). DNA barcodes: methods and protocols. Methods in Molecular Biology (Clifton, N.J.), 858, 3–8. https://doi. org/10.1007/978-1-61779-591-6_1
• Mattiello, D. S., & Gazzaroli, M. (n.d.). UNIVERSITÀ DEGLI STUDI DI MILANO Corso di Laurea in VALORIZZAZIONE E TUTELA DELL’AMBIENTE E DEL TERRITORIO MONTANO IL CINGHIALE NEL BASSO CHIESE TRENTINO.
• Meneguz, P. G.. Gestione del cervo in Italia: quali prospettive. Atti convegno nazionale Pisa 27 settembre 2019. La fauna selvatica nelle produzioni animali: aspetti gestionali e sanitari. Moreira, M. J., García-Díez, J., de Almeida, J. M. M. M., & Saraiva, C. (2021). Consumer Knowledge about Food Labeling and Fraud. Foods (Basel, Switzerland), 10(5). https://doi.org/10.3390/ FOODS10051095
Neto, L., Pinto, N., Proença, A., Amorim, A., & Conde-Sousa, E. (2021). 4SpecID: Reference DNA Libraries Auditing and Annotation System for Forensic Applications. Genes, 12(1), 1–15. https://doi.org/10.3390/GENES12010061
Silva, T. L., Godinho, R., Castro, D., Abáigar, T., Brito, J. C., & Alves, P. C. (2015a). Genetic identification of endangered North African ungulates using noninvasive sampling. Molecular Ecology Resources, 15(3), 652–661. https://doi. org/10.1111/1755-0998.12335
• Silva, T. L., Godinho, R., Castro, D., Abáigar, T., Brito, J. C., & Alves, P. C. (2015b). Genetic identification of endangered North African ungulates using noninvasive sampling. Molecular Ecology Resources, 15(3), 652–661. https://doi. org/10.1111/1755-0998.12335
The European Union One Health 2019 Zoonoses Report. (2021). EFSA Journal, 19(2). https://doi. org/10.2903/J.EFSA.2021.6406
Ward, R. D. (2012). FISH-BOL, a case study for DNA barcodes. Methods in Molecular Biology (Clifton, N.J.), 858, 423–439. https://doi. org/10.1007/978-1-61779-591-6_21
• Ward, R. D., Hanner, R., & Hebert, P. D. N. (2009). The campaign to DNA barcode all fishes, FISH-BOL. Journal of Fish Biology, 74(2), 329–356. https://doi.org/10.1111/J.10958649.2008.02080.X

Giuseppe L. Pastori - Tecnologo Alimentare
Cominciamo con il dire che l’impiego dei pistacchi nella mortadella non è obbligatorio: il disciplinare di produzione della Mortadella IGP ammette sia la versione con pistacchi che quella senza. Inoltre, l’accettazione del salume in diverse parti d’Italia è diversa, perché in fondo è sempre una questione di gusti: nel bolognese infatti si preferisce quella senza pistacchi, mentre a Milano, Roma, nel centro e sud Italia avere questo ingrediente rappresenta un valore aggiunto, perché impreziosisce la ricetta conferendo un sapore più intenso e una consistenza più croccante quando si “incontra” il pistacchio (a patto che ce ne siano e non sia solo una presenza una tantum…). Inoltre questo pregiato frutto dà un tocco di colore alla mortadella e per alcuni rappresenta per l’appunto un must. Nella salumeria il pistacchio lo si usa anche in altre specialità a produzione regionale come la galantina, un salume natalizio che viene prodotto principalmente nelle Marche e in Lombardia. Se nel centro Italia è prevalentemente a base di pollo, in Lombardia (soprattutto in terra ambrosiana) è a base di vitello: la sua preparazione prevede l’impiego della spalla di vitello snervata e della lonza di maiale, disposte longitudinalmente in uno stampo con grasso duro, e farcita con tartufo nero (che fa bella mostra di sé al centro della fetta) e, appunto, il pistacchio.
Originaria dell’Asia Minore, la pianta del pistacchio è coltivata fin dai tempi antichi nel bacino Medio Orientale (il frutto è citato anche nella Bibbia come prodotto della terra). Oggi i maggiori produttori sono la Turchia e l’Iran, oltre alla California.
Ad introdurla in Italia sono stati gli Arabi, che ne hanno iniziato la coltivazione nelle regioni meridionali, grazie al clima particolarmente favorevole. Una produzione significativa si è sviluppata soprattutto in Sicilia, alle pendici dell’Etna dove il suolo vulcanico si è dimostrato essere particolarmente adatto alla crescita della pianta. Molto apprezzata è la produzione del pistacchio di Bronte, che si avvale della denominazione d’origine DOP e che concorre per circa l’1% all’intera produzione mondiale.
Nelle regioni del Mediterraneo il pistacchio ha una particolare rilevanza culinaria. In Sicilia il suo impiego in cucina è molto diffuso e viene utilizzato per preparare dolci come il Cannolo siciliano e la Cassata, ma lo si usa anche in molte altre regioni del paese per arricchire antipasti, primi e secondi piatti, sia dolci che salati, e nel gelato.
Nella produzione delle specialità di salumeria in Italia, l’uso del pistacchio ha probabilmente avuto origine nel Rinascimento, come ingrediente per arricchire alcune ricette. Tuttavia Vincenzo Tanara, nel suo celebre trattato del 1644 – l’Economia del Cittadino in Villa (che per inciso non parla di
cucina ma di amministrazione di una tenuta di campagna), descrivendo la prima ricetta codificata della mortadella, non menziona il pistacchio tra le varie spezie utilizzate, mentre cita pepe, cannella, chiodi di garofano, noce moscata e grani di muschio. Del resto non si può nemmeno pensare che questo ingrediente sia stato presente nelle produzioni tipiche contadine per soddisfare il fabbisogno della famiglia, quanto più in quelle più commerciali e da presentare sulle tavole di un ambiente più ricco. Bisogna infatti rilevare che, dato il costo della materia prima in sé, oggi come ieri, la valenza d’impiego del pistacchio è duplice: è usato infatti sia come ingrediente caratterizzante nei prodotti in cui viene aggiunto per conferire un sapore unico e inconfondibile, sia per curare la presentazione estetica perché il colore verde tipico del frutto contribuisce a rendere la mortadella più invitante e riconoscibile. Occorre però tenere in considerazione due problematiche legate all’uso dei pistacchi: la prima, che nei frutti importati (in particolare in quelli provenienti dall’Iran) possono essere presenti delle aflatossine; la seconda, che il pistacchio rientra tra gli alimenti allergenici e come tale va opportunamente dichiarato in etichetta. Le aflatossine sono sostanze cancerogene prodotte da alcuni tipi di funghi che possono contaminare i pistacchi. Si formano quando esistono condizioni favorevoli rappresentate da una tempera-
tura intorno ai 30°C e da un forte tasso di umidità. Queste condizioni possono verificarsi per carenze igieniche durante la conservazione e il trasporto delle merci via nave e quindi esiste il pericolo potenziale di produzione di “ammuffimento”: per questo motivo le Autorità di controllo prestano molta attenzione alle merci di importazione. Questo rischio è particolarmente elevato nei paesi dove le normative sulla sicurezza alimentare sono meno rigorose. Le aflatossine possono essere nocive per la salute umana se ingerite in quantità rilevanti, provocando danni al fegato e aumentando il rischio di sviluppare alcuni tipi di tumori. Le leggi vigenti pongono restrizioni severe sulla quantità di aflatossine accettabile negli alimenti e il loro superamento implica la distruzione dei prodotti. Grazie alla presenza di tali norme, c’è un elevato livello di sicurezza per la frutta secca (pistacchi, arachidi, noccioline, ecc.). Come già accennato, la formazione di muffe negli alimenti può essere risolta attraverso un corretto stoccaggio in ambienti asciutti e ben refrigerati. Tuttavia, queste condizioni non sono sempre possibili per le merci importate e quindi è necessario effettuare controlli frequenti e precisi. Spesso comunque, le materie prime arrivano allo stato grezzo e devono essere trasformate industrialmente; è compito delle industrie di trasformazione prevenire la contaminazione delle materie prime di qualità inferiore con quelle di migliore qualità. I pistacchi italiani, ad esempio, sono di ottima qualità e non richiedono lunghi viaggi, pertanto possono essere considerati più sicuri rispetto a quelli importati, almeno per quanto riguarda la presenza di aflatossine, anche se hanno costi superiori. Un altro problema rilevante legato all’impiego dei pistacchi è la loro natura di allergene potenziale. I pistacchi rientrano infatti tra i principali alimenti che possono causare allergie nel cibo, insieme a cereali contenenti glutine, uova, latte, pesce, crostacei, frutta a guscio, sedano e senape. La loro presenza nella mortadella deve quindi essere sempre indicata chiaramente sull’etichetta, al fine di evitare possibili reazioni allergiche in persone sensibili.


Alimentazione e genetica sono i segreti per la crescita di un maiale che presenta carni dalle caratteristiche uniche e fornisce l’ingrediente base per la lavorazione di salumi straordinari per qualità e note organolettiche
La storia del Maiale Tranquillo® è un viaggio e, come un viaggio ideale, attraversa luoghi e dimensioni, percorre vie reali e immaginarie, ha un inizio e un punto d’arrivo. Ma ogni passo è un momento speciale, uno spazio temporale con una sua ragione precisa,
un lasso di tempo durante il quale l’oggetto del viaggio si trasforma fino a raggiungere la perfezione.
Il Maiale Tranquillo® della famiglia Bettella è innanzi tutto un progetto di vita che nasce dall’intuizione e dall’esperienza di Giuseppe Bettella, una storia di imprenditoria agricola e studi di medicina, una visione innovativa che l’hanno portato, all’inizio degli anni duemila, a creare un allevamento di suini extra pesanti dalle caratteristiche uniche.
“In famiglia abbiamo sempre avuto idee innovative – racconta Giuseppe Bettella – pensate che nel 1953 siamo stati i primi a utilizzare la mietitrebbia nei nostri campi e mio padre fu l’inventore della granella umida per l’alimentazione degli animali. Negli anni settanta, mentre andavo all’università, con 3 amici ebbi l’idea di costruire una scrofaia in un appezzamento

agricolo: ci recammo in Olanda dove comprammo 3 verri e 6 scrofe e fummo i primi ad allevare le scrofe in gabbia. Tutto nasce da lì”. A Gabbioneta Binanuova, in provincia di Cremona, dove ha sede l’Azienda Agricola Bettella, negli anni sessanta esiste già un’azienda con una sessantina di maiali ospitati in un caseificio dismesso; poi negli anni ottanta arrivano le galline e i maiali aumentano fino ad arrivare a 750 allevati a ciclo chiuso. Intanto, periodicamente, i Bettella si dedicano all’allevamento di vacche, alla coltivazione di tabacco, di lino, di mais monocoltura. Lo stesso mais che ancora oggi costituisce l’alimentazione dei suini. Continua il suo racconto Giuseppe Bettella: “Quando decisi di concentrare l’allevamento sui suini decisi anche che avrei impostato il processo come lo volevo io, in un modo diverso da quello convenzionalmente adottato. Ho sempre avuto la passione per i salumi e grazie ai miei studi ebbi modo di approfondire gli aspetti legati all’alimentazione e alla genetica degli animali. Questi studi si sono rivelati fondamentali per impostare un metodo rivoluzionario per l’epoca. Ho testato così la corrispondenza dell’alimentazione e della genetica sulla carne e ho potuto quantificare la loro influenza sulla qualità della stessa (per esempio non compero il mais per il mangime ma lo coltivo nei miei campi come voglio io) e ho cominciato a giocare. Portavo la carne nei diversi salumifici e facevo realizzare i salumi di cui, poi, testavo la qualità. Ogni salumificio ha un suo metodo di lavorazione e questo è fondamentale per la riuscita del prodotto finito. Esperienza, conoscenza dell’arte della norcineria sono valori e io ho scelto i migliori artigiani per ogni specialità. Perché un agricoltore può anche fare un salame se vuole ma non possiederà la maestria del norcino. È per questo che ogni salume realizzato con le nostre carni viene

lavorato presso salumifici selezionati e specializzati”.
DAL CASO, UN’INTUIZIONE GENIALE
La scelta è quella di realizzare prodotti di alta qualità perché, afferma Bettella: “Non si può fare concorrenza all’industria, noi facciamo qualità e non quantità”.
La svolta definitiva avviene nel 2008 quando Giuseppe Bettella, insieme al figlio Stefano, decide di sfruttare quello che potrebbe sem-

brare un momento di crisi, la malattia vescicolare suina all’epoca diffusa. “I nostri maiali erano sani – spiega Bettella – ma la lavorazione era bloccata. I nostri maiali crescevano, aumentavano di peso, così decisi di macellarne alcuni e portarli a San Daniele dove realizzammo alcuni prosciutti presso un salumificio nostro partner. Stagionato sul posto, ne deriva un prosciutto eccezionale e siamo consapevoli che il peso conta. E così, da un maiale di circa 150 kg siamo passati a un animale di 370-380 kg, che deve essere macellato in un macello bovino. Da questo esperimento, e da questa intuizione, è nato il nostro Maiale Tranquillo®”.
Le dimensioni dell’animale attribuiscono alla carne un sapore più profondo, dal gusto intenso, “è come mangiare un Parmigiano di 50 mesi” spiega Giuseppe Bettella. Il profumo poi è unico.
“Abbiamo cominciato a produrre salumi con maiali extra pesanti e ci siamo accorti della differenza. Abbiamo studiato apposta un metodo di stagionatura che arriva anche a 60-80 mesi – racconta Bettella –; quest’anno al Cibus di Parma abbiamo aperto un prosciutto stagionato 12 anni che si è rivelato perfetto. Il nostro prosciutto può essere paragonato allo spagnolo Pata Negra per la percentuale di acido oleico che possiede; quando tagli la fetta il grasso cola, ne senti il sapore avvolgente, non ha difetti, è morbido come burro”.
Il sapore e la consistenza delle carni, la salubrità del grasso (che contiene oltre il 50% di acido oleico, simile all’olio d’oliva, grazie alla genetica e all’alimentazione a base di soli cereali coltivati e tostati dall’azienda Bettella) imprimono
ad ogni taglio destinato alla produzione norcina un carattere unico, che richiede grande attenzione e maestria nella lavorazione e nella stagionatura.
Non solo prosciutto, ovviamente, perché dal Maiale Tranquillo® si ottengono molti prodotti di altissima qualità, dai wurstel allo speck, dalla pancetta al prosciutto cotto, coppa, carne salada o prodotti affumicati. La macellazione avviene in macelli specializzati dove il processo viene seguito dalla squadra di Bettella che si occupa della lavorazione. Poi, la carne viene inviata ai salumifici selezionati in base al prodotto che si desidera ottenere.
Il Maiale Tranquillo® intraprende così un viaggio verso le terre dove dimorano i grandi norcini italiani che, grazie alla loro esperienza, sono in grado di trasformare una grande materia prima in un grande salume, esaltandone le qualità organolettiche. La collaborazione tra l’azienda Bettella e i diversi artigiani norcini italiani è un esempio virtuoso di valorizzazione del made in Italy. I salumi di Maiale Tranquillo® sono una vera e propria espressione della cultura gastroATTUALITÀ


nomica italiana, che unisce tradizione a qualità, sostenibilità, gusto e antichi saperi. Non è un prodotto comune, non è per tutti, perché il suo prezzo è elevato ed è importante saperne apprezzare le qualità. L’azienda Bettella si rivolge per la commercializzazione prevalentemente alla ristorazione e alle botteghe d’alto livello: una fascia di consumatori ristretta forse ma assolutamente competente. Del resto il marchio registrato garantisce e identifica una filosofia di produzione ineguagliabile, una filiera sostenibile e accuratamente seguita, oltre ogni logica di prezzo.
Con il progetto Maiale Tranquillo®, l’Azienda Agricola Bettella ha creato una filiera ecosostenibile e innovativa, che unisce il benessere animale, la qualità delle materie prime, la valorizzazione del territorio e la salvaguardia dell'artigianalità.



Ufficiali per l’Italia





Davide Ubaldi è “figlio d’arte” e il mestiere l’ha appreso dalla famiglia che, dai primi anni novanta, svolge l’attività di macelleria tra Urbino e Casinina di Sassocorvaro.
Lo scorso mese di giugno, l’inaugurazione di un nuovo punto vendita a Mercatale. “Ci troviamo in una zona strategica e molto rinomata per la qualità dei suoi prodotti – racconta Ubaldi – perché siamo sull’Appennino centrale, nel cuore del Montefeltro, al confine tra le Marche, la Romagna e l’Umbria. Selezioniamo le carni migliori del territorio, dalla Chianina alla Romagnola, dalla Marchigiana al Vitellone Bianco dell’Appennino centrale Igp. Ci riforniamo da aziende agricole della zona, macelliamo sul territorio e lavoriamo personalmente tutto l’animale nei nostri laboratori dove produciamo anche salumi tipici. La carne del Montefeltro, allevata e lavorata secondo tradizione è per noi un vanto e la proponiamo ai nostri clienti affinché possano gustare i sapori genuini di una volta”. Dal fresco al cotto, i tagli più pregiati e i preparati pronti da cuocere, i salumi artigianali –come il salame e il prosciutto crudo - e piatti cucinati secondo la tradizione della cucina locale, ricca di specialità tipiche. “Il nuovo negozio nasce proprio per offrire alla clientela la possibilità di gustare le nostre specialità sul posto. Infatti abbiamo allestito una zona somministrazione, con pochi posti a sedere ma ben disposti, dove serviamo aperitivi e piatti veloci per la pausa pranzo. L’idea sarebbe quella di organizzare anche piccoli eventi di degustazione serali per far conoscere l’eccellenza dei prodot-
Un nuovo concetto di macelleria, dove la qualità della carne è al primo posto. Le razze più prestigiose d’Italia, aziende agricole biologiche e il Montefeltro con la sua gastronomia, per gustare aperitivi e piatti gourmet in un ambiente confortevole e funzionale
ti, il corretto abbinamento coi vini, insomma, fare un po’ di cultura gastronomica. Ci piace l’idea di diffondere la conoscenza dei prodotti tipici, dimostrare la qualità del nostro lavoro. Anche per questo il nuovo negozio prevede il laboratorio adiacente a vista: chi entra può vedere attraverso la grande vetrata che separa gli ambienti la lavorazione della carne, dal disosso alla preparazione, alla cottura”.
Un aperitivo coi salumi, un primo piatto condito col ragù fatto con le carni genuine della macelleria Ubaldi, le carni cotte alla brace o al bbq. Dice Davide Ubaldi: “Alla gente piace vedere come lavoriamo, e del resto è interessante osservare la preparazione perché noi trattiamo tutto l’animale dai tagli pregiati a quelli meno nobili. La cucina del territorio prevede molti piatti a base di quinto quarto per esempio, e noi dimostriamo che quello che portiamo in tavola, od offriamo nel nostro banco di gastro-
Uno stile sobrio e lineare, che vuole mettere in evidenza il legame con la tradizione e valorizzare lo sviluppo contemporaneo del concetto di macelleria
nomia, proviene dalla lavorazione diretta”. Una bottega di 120 mq con un bel bancone refrigerato che permette di mettere in bella mostra e conservare perfettamente le specialità della macelleria. L’allestimento del nuovo negozio è stato affidato a Criocabin e ai suoi partner, Merli Arredamenti e la Designer Danila


Dominici, che hanno studiato la funzionalità dell’ambiente e fornito le attrezzature più adatte: un banco Enixe 200 con piano lavoro da 36 cm e Enixe 200 ad angolo chiuso a 90°.
Uno stile sobrio e lineare, che vuole mettere in evidenza il legame con la tradizione e valorizzare lo sviluppo contemporaneo del concetto di macelleria. Racconta Ubaldi: “Ci piaceva l’idea di prendere spunto dal passato con un banco dall’aria un po’ retro, ma di rinnovarne lo stile riportandolo nel 2024 con un colore moderno e linee d’impatto. La tradizione spesso si va perdendo, noi vogliamo mantenerla traducendone le caratteristiche come si conviene al nostro periodo storico”. Vedere e toccare con mano la qualità, dunque, perché quando la professionalità è alta si manifesta anche nella semplicità con cui viene messa in pratica. “Nasce tutto dalla passione che ci mettiamo – dichiara Davide Ubaldi – ogni giorno. Autenticità e qua-

lità sono alla base del nostro lavoro. Vogliamo celebrare il nostro territorio e offrirlo nella sua specificità. In questo nuovo negozio, così bello e accogliente, chi entra si sente a suo agio ed è questo che vogliamo”.
La carne del Montefeltro, allevata e lavorata secondo tradizione è un vanto da proporre ai clienti affinché possano gustare i sapori genuini di una volta


Il sistema di refrigerazione con impianto a bordo a glicole.
Il calo della carne è inferiore del 50% rispetto a un normale banco ventilato. 9.000 € è il risparmio, in media, in un anno. Con G-Concept, inoltre, la carne può rimanere nel banco durante la notte: 720 ore di lavoro risparmiate, pari a 14.400 €
Andrea Rinaldi è il giovane chef che dopo una decennale carriera in ristoranti rinomati a Roma e all’estero, decide di continuare il suo percorso professionale ritornando alle sue radici nel Lazio per creare qualcosa di speciale guidato dalla passione per la cucina autentica e stagionale.
Insieme alla moglie Isabella Capriotti apre Nuh Osteria Contemporanea, nella natia Tivoli, dove ritrova una cucina sostenibile, il racconto di un territorio ricco di tradizioni e genuinità. Il risultato sono piatti che trasudano passione, creatività e un profondo rispetto per gli ingredienti.
Racconta Andrea: “Ci piaceva l’idea di concentrare la nostra ricerca della genuinità sulle persone. Noi siamo al servizio dell’ingrediente e per noi è un impegno studiare i prodotti e sceglierli secondo l’identità della gente che li produce. È per questo che lavoriamo con tanti piccoli produttori: perché crediamo che quando ci si approccia alla qualità di grandi materie prime che nascono dal rispetto e dall’impegno di chi le lavora questo debba essere valorizzato”.
Nuh fonda le sue basi sull’Azienda Agricola Capriotti, della famiglia di Isabella, e sui suoi prodotti sempre freschi che si ritrovano a

Il calore dell’osteria, l'informalità della convivialità e l'eleganza della cucina contemporanea sono i tratti identitari di Nuh Osteria Contemporanea, nel centro storico di Tivoli
tavola, dalle verdure agli ortaggi fino all’olio. “In questo siamo fortunati – afferma Andrea – ma non sempre abbiamo tutto a disposizione, quindi cerchiamo di ampliare le nostre conoscenze e trovare i migliori prodotti da portare sulla nostra tavola. Come i cereali che impieghiamo per i lievitati,
solo farine da grani antichi dell’Azienda Agricola La Viola, come le carni per i piatti cotti che ci vengono fornite da The Wolf e le carni per le preparazioni a crudo per le quali ci affidiamo al consorzio Coalvi. I miei piatti sono composti di pochi ingredienti, 2 o 3, massimo 4 elementi ma devono essere il

meglio che posso trovare e voglio esaltarli lavorandoli con rispetto. Quando gli ingredienti sono pochi non si crea confusione coi sapori e il cliente si ritrova in grado di riconoscerli distintamente, li va a ricercare dopo averli letti nel menù. Per noi è un impegno offrire la risposta adatta”. Questa filosofia guida ogni step del percorso di lavorazione, valorizza la proposta culinaria di Nuh ed è frutto di attenta riflessione che Andrea Rinaldi così giustifica: “I primi 8 anni della mia vita lavorativa li ho trascorsi nelle cucine di chef stellati, sia in Italia sia all’estero, è lì mi sono reso conto che esistono tante sovrastrutture fini a loro stesse ma che all’atto pratico non fanno onore alla materia prima, anche se eccellente. Secondo me non ha senso inseguire una stella solo per la fama. Io mi sono distaccato da questa realtà, ci ho guardato dentro e non mi è piaciuta, non è cucina. O meglio, non è la cucina che io voglio fare. Siamo giovani ma siamo consapevoli di essere sovrastati da una forma di marketing schiacciante che tende ad appiattire la ricerca

che invece vogliamo e possiamo fare. È una scelta di vita”.
Per le carni cotte, chef Rinaldi usa solo vacche di Frisona, animali oltre i 3 anni di età, fornite da un’azienda che sta attuando un grande lavoro di riqualificazione su tutte le razze italiane, che in Italia sono una cinquantina ma di cui di solito se ne utilizzano meno di dieci. Tra le razze trattate, per esempio, The Wolf alleva in maniera estensiva le vacche provenienti dagli allevamenti Granarolo che, dismesse a 2 anni di età, vengono allevate in Emilia Romagna al pascolo fino ai 5-6 anni. “Diventano animali straordinari e forniscono un prodotto eccezionale – afferma Andrea. – La Frisona è una razza che andrebbe rivalutata, offre poca resa e per questo viene scelta raramente dai macellai ma le sue carni hanno una salinità e una sapidità eccezionali soprattutto se portate a una stagionatura importante: un animale di questa età ha un sapore intenso, unico”.
Andrea Rinaldi acquista l’intera mezzena e la lavora personalmente. Allo stesso modo, sempre dalla stessa azienda, compra selvaggina selezionata intera, oppure capretti e agnelli. “Ho imparato a disossare e sezionare con l’esperienza in cucina, per passio-
ne – spiega Andrea – e in questo modo ottimizzo ogni acquisto perché utilizzo all’interno del menù tutto l’animale in ogni sua parte. Dalla costata ricavo anche la parte intercostale per fare degli spiedini; dalla copertina ricavo un grasso di vacca chiarificato e montato che può essere servito come un burro o utilizzato nella mantecatura di un risotto oppure per scottarci la carne. La scottata di Fassone che, per sua natura, è molto magra la cucino ungendo la padella con questo grasso chiarificato. In una vacca ce n’è tanto di grasso e io lo uso tutto. Con le ossa preparo un fondo. Questo aggiunge valore al piatto e alla cucina, anche dal punto di vista economico. Certo tutto questo viene controbilanciato con lunghe ore di cottura, costi di lavorazione e di personale, non è semplice, ma quanta soddisfazione!”.
È dunque una sorta di stile di vita, quello che Andrea e Isabella hanno adottato, non solo dal punto di vista professionale per lo sviluppo della loro attività – fattore fondamentale - ma in quanto approccio alla costruzione di un sistema

orientato al futuro. Sostenibilità non è solo una parola e richiede impegno, spiega Andrea: “La sostenibilità vera è difficile, perché comporta il fatto di non avere tutti i giorni lo stesso prodotto a disposizione. Facciamo un esempio: voglio cucinare Frisona ma non c’è, allora devo utilizzare una Duchessa e devo far capire tutto questo al cliente che, ipotizzo, magari è arrivato da Nuh proprio per la Frisona. A questo punto devo essere in grado di spiegare al cliente che la Duchessa, razza autoctona della Sicilia, è ottima tanto da essere soprannominata
‘la rubia italiana’. È un metodo di lavoro che richiede una strategia di comunicazione ben studiata perché il rischio di non essere compresi e pertanto scartati dal cliente è elevato. Quindi, vuol dire anche selezione della clientela; vuol dire ricerca assidua, ovvero affidarsi invece che a un fornitore alle persone. Non è accostabile alla quantità, ma alla qualità perché essere sostenibili vuol dire esserlo in tutto: dalla scelta di un detersivo al rifiuto di impiegare certi prodotti chimici. Tutto questo ha un costo ma è una scelta, quella di supportare chi lavora bene”.


IL MENÙ, UNA SINFONIA
DI SAPORI
“Osteria è il calore dell’informalità ma anche la sorpresa delle stagioni. Sedersi a tavola senza sapere cosa la cucina ha in serbo per gli ospiti” dice Andrea. Il menù è una sinfonia di sapori, texture e profumi, un'esperienza culinaria che segue il ritmo delle stagioni e che, anzi, varia anche ogni 4/8 settimane.
In carta il menù propone anche tre percorsi degustazione: mare, terra, vegetale, con 4 portate più la piccola pasticceria. I menù degustazione non vanno però intesi come “fissi” perché verranno cuciti su misura del cliente, in base ai suoi gusti e alle sue esigenze. Tra i piatti che fin dall’apertura hanno dato grandi soddisfazioni, la tartare di scottona piemontese con sopra una brace di porro
e servita con brodo speziato con spezie mediterranee italiane dalla liquerizia al ginepro; o anche la vacca alla cenere servita con erbe amare ripassate al ferro in padella con aglio, olio e peperoncino e servita con emulsione di bagna cauda. “È un piatto che riprende lo stile tipico alla romana di aggiungere l’acciuga nel soffritto ma lo rendiamo più elegante e avvolgente con l’emulsione di bagna

cauda. Serve molta lavorazione e studio perché la vacca viene fatta maturare nella cenere: prendo la costata e la disosso, faccio maturare il pezzo che andrò a porzionare all’interno di una cenere vegetale edibile realizzata con gli scarti degli ortaggi abbrustoliti e ripassati in forno a 100°, poi frullati e ridotti in polvere. Questo piatto rappresenta il concetto di sostenibile e zero sprechi: le bucce dell’aglio, della cipolla e delle carote vengono utilizzate per la cenere e tutte le parti della vacca vengono utilizzate, da quella per il ragù alla costata” spiega lo chef.
Nuh si impegna a lasciare un'impronta positiva nel territorio. Non solo carne: per il pescato si appoggia sul pesce del litorale tirrenico, da Ponza fino a Porto Santo Stefano e la carta dei vini offre un viaggio attraverso le migliori referenze regionali d'Italia, con una particolare attenzione alle gemme vinicole del Lazio. Sono oltre 250 le etichette che Isabella, maitre e sommelier Ais, consiglia agli ospiti insieme alle circa 40 referenze di distillati.
È molto più di un semplice ristorante; è un'esperienza culinaria straordinaria che celebra l'autenticità, la creatività e il rispetto per l'ambiente: “Il prodotto finito parla da sé” conclude Andrea

Quanto sia importante, per una macelleria alla ricerca del successo, identificare con il proprio nome quanto si produce lo si trova nella prima pagina di ogni manuale di marketing.
Allo stesso modo, sarebbe più opportuno dare il proprio nome a tutti quei prodotti che non possono essere direttamente prodotti da noi, ma sono materie prime che poi trasformiamo ed elaboriamo in base alla nostra capacità, esperienza e fantasia. Appare così evidente che esiste un comune denominatore, tra queste due attività all’apparenza diverse, e possiamo chiamarlo “professionalità”.

La professionalità è una vera qualità, aggiunge alla materia prima quegli elementi, frutto dell’esperienza, migliorando il prodotto.
Non sto parlando di mescolare vari elementi, questo è un passaggio successivo, parlo di scegliere: il manzo giusto, con le sue peculiarità di grasso e magro; la giusta frollatura, che non è un calcolo algebrico ma un’attenzione che solo gli occhi del macellaio possono avere ed è frutto di quella professione esperta che crea qualità; la sapienza del taglio, dove riconoscere le fibre significa offrire tagli perfetti a soddisfazione delle esigenze del consumatore.
Ma significa anche non sprecare, valorizzare tutti i tagli della carcassa, dare il giusto valore economico rendendo così economici alcuni dei prodotti che poi verranno esposti nel banco, senza rinunciare alla preziosità di questo nutrimento fondamentale.
Così io vedo il futuro della nostra professione. Qualcuno sta dicendo che noi siamo così da sempre? Infatti, costruire il futuro sull’esperienza e sulla nostra storia è fondamentale.
Credo però necessario un altro passo che può sembrare all’indietro. Dobbiamo consolidare le nostre radici, quelle che ci hanno portato a visitare le stalle, a scegliere sul campo il bestiame giusto per la nostra professionalità.
Creando una alleanza con piccoli e medi allevatori e portando a conoscenza dei consumatori, attraverso la voce dei macellai, le storie di persone che quotidianamente sono impegnate a creare una carne sicura, etica e buona, allevando con cura i propri animali, per soddisfare le esigenze del consumatore di oggi e domani. Quel consumatore che vorrebbe mangiare serenamente, ma è distratto dalle continue fake news dei social.
Invece è necessario rivolgersi alla scienza, collaborando con le Università, per avere una voce chiara, univoca e onesta che parli ai consumatori e li rassicuri della carne che mangiano e dei suoi valori nutraceutici essenziali.
Questo l’impegno di FEDERCARNI per il prossimo futuro, costruire un sistema che dia certezze a consumatori, allevatori e macellai.
Maurizio Arosio, Presidente Federcarni

Dal Vitellone Bianco dell’Appennino Centrale IGP un questionario dedicato ai consumatori e alla conoscenza del marchio per conoscere le abitudini dei consumatori e per raccogliere le loro opinioni sulla carne bovina e sui marchi DOP e IGP.
È quello che il Consorzio di Tutela Vitellone Bianco dell’Appennino Centrale IGP ha pubblicato sul proprio sito, per coinvolgere gli utenti che ricercano l’eccellenza e la qualità a tavola facendo la spesa o consumando la carne al ristorante o in altri luoghi. Le risposte al questionario saranno analizzate dal Consorzio e presentate nel corso di un’iniziativa riservata ai soci.
“Il questionario – ha spiegato Andrea Petrini, direttore del Consorzio di Tutela Vitellone Bianco dell’Appennino Centrale IGP – è stato preparato con l’obiettivo di scoprire il grado di conoscenza e la propensione all’acquisto dei consumatori verso i prodotti a marchio DOP e IGP, con una particolare attenzione per la scelta e l’acquisto della carne bovina. Le risposte che raccoglieremo saranno molto importanti per l’attività di promozione che svolge il nostro Consorzio. Solamente conoscendo le abitudini e le esigenze dei nostri consumatori, infatti, possiamo valorizzare in maniera efficace le

peculiarità della carne certificata Vitellone Bianco dell’Appennino Centrale IGP che la rendono unica da sempre e che, da oltre 25 anni, ne fanno un prodotto di qualità certificato e tutelato dal marchio IGP”.

MEatSCHOOL, l’Academy dedicata alla formazione, informazione e diffusione della cultura della carne bovina, ha recentemente siglato nuove partnership con alcune realtà aziendali leader del settore della ristorazione: da segnalare l'inizio della collaborazione con Electrolux Professional Chef Academy. Tale collaborazione permetterà ai docenti MEatSCHOOL e ad un team di oltre 70 mentori culinari provenienti da diverse parti del mondo dell’Academy Electrolux, di scambiare conoscenze e sperimentare continuamente, con l'obiettivo di valorizzare al massimo la materia prima.
A completare questa collaborazione si inserisce l’accordo con Zanussi Professional, che metterà a disposizione del progetto i suoi migliori dispositivi all’interno della cucina professionale di MEatSCHOOL.
Da segnalare anche la collaborazione con Carpigiani Gelato University e Italpepe: in occasione di Cibus 2024 "formazione e innovazione" si sono incontrate nella presentazione di un abbinamento innovativo: la battuta di carne You&Meat - il brand di Centro Carni Company, l’azienda di Tombolo (PD) adiacente alle aule formative MEatSCHOOL - è stata aromatizzata con diverse spezie, dalle più tradizionali italiane a quelle con influenze orientali, ed abbinata a uno straordinario gelato gastronomico all'olio d'oliva e passion fruit.
Una carne “Buona per Natura” e ora anche IGP: la Commissione Europea ha recentemente riconosciuto lo status di Indicazione Geografica Protetta (IGP) all'Irish Grass Fed Beef. La certificazione IGP premia l’esperienza delle aziende agricole locali e il contributo dei rigogliosi pascoli irlandesi nella produzione di una carne di qualità.
E per gli stessi motivi, i membri dello Chefs’ Irish Beef Club, associazione che riunisce chef riconosciuti a livello internazionale che condividono una passione comune: la carne di manzo irlandese, sostengono il progetto di Bord Bia, riconoscendo il valore della produzione agroalimentare irlandese: pratiche di allevamento tradizionali, tramandate di generazione in generazione - bovini allevati all’aperto per un minimo di 220 giorni all’anno e alimentati per almeno il 90% con erba. La tracciabilità, la sostenibilità e il benessere animale sono aspetti che rendono la carne bovina irlandese Grass Fed una delle più apprezzate al mondo.
Proprio in occasione dei primi vent’anni del CIBC, i membri del Club si sono riuniti in Irlanda per scoprire in prima persona le novità relative all’IGP. Chi sono gli chef italiani che hanno scelto di diventare ambasciatori della carne bovina irlandese Grass Fed?
• Stefano Arrigoni (Osteria della Brughiera, Villa d’Almé, BG), 1 stella Michelin
• Francesco Cassarino (Consulting Chef)
• Alberto Canton (Bocon Divino, Camposampiero, PD)
Sara Conforti (LHP Hotel Certaldo, Certaldo, FI)
• Stefano Di Gennaro (Quintessenza Ristorante, Trani, BT), 1 stella Michel
• Andrea Fusco (Bistrot Roma Luxus, Roma)
• Federico Pettenuzzo (La Favellina, Malo, VI), 1 stella Michelin
• Daniele Repetti (Nido del Picchio, Carpaneto Piacentino, PC)
Filippo Saporito (La Leggenda dei Frati, Firenze)
• Paolo Trippini (Ristorante Trippini, Civitella del Lago, TR)

Dopo il Covid in tanti commentano e affermano che il settore della ristorazione è cambiato o qualcosa non è più la stessa; di certo alcune situazioni si sono modificate. Il personale è una voce sempre più presente nel tema del cambiamento: si allungano i giorni di riposo, almeno due la settimana; chi ci riesce, assume per il servizio del pranzo o della cena, per riuscire ad attrarre nuovo personale; il tempo sembra, anzi è, il nuovo motivo che giustificherebbe la carenza di personale.
Il rischio imprenditoriale è un aumento dei costi di gestione ma, in ogni caso mancano soprattutto candidati e collaboratori specializzati e il caso della carne riportato agli inizi del presente è una motivazione reale.
Oggi trovare cuochi in grado di disossare un carré, pulire un filetto o una coscia è molto difficile e nel settore ittico, cioè il pesce, la problematica è molto più pressante. Questo ha portato le aziende del settore, dai semplici grossisti alle aziende specializzate multi-
prodotto per l’alta ristorazione, a produrre e offrire tagli di carne già sezionati, porzionati nel peso desiderato e richiesto anche sottovuoto con una gamma molto ampia; a Milano, ormai anche le costolette di vitello per la versione famosa della Milanese, sono preparate secondo il peso richiesto e messe sottovuoto singolarmente. Al Cuoco non rimane che toglierla dal sottovuoto e prepararla secondo la ricetta.
Ma un altro fenomeno in crescita è la presenza nei ristoranti di vetrine frigorifero, che offrono carne in stato di frollatura e maturazione, carni spesso di varie provenienze con l’obiettivo di stimolare il cliente a una scelta più ampia e attenta secondo i propri gusti e desideri, ma nei casi dei più esigenti anche per una scelta emozionale. Forse è arrivato il momento di scoprire e cercare nuove strade che possano agevolare il ristoratore in una scelta commerciale più comoda e veloce.
Le macellerie sono un presidio del territorio da riscoprire e ripromuovere; in fondo il macellaio è un fornitore di fiducia ma anche un conoscitore del territorio in cui
CHI È MATTEO SCIBILIA…
Chef e Ristoratore da oltre 40 anni a Milano e provincia, dirigente FIPE e delegato Confartigianato Lombardia, docente di scuole alberghiere.

opera; spesso è un grande professionista specializzato. La domanda è: perché non far incontrare ristoratori e macellai?
Quest’ultimo – il macellaio – è già preparato a sezionare, tagliare, pulire e servire il cliente tradizionale, cioè la famiglia; non ha o non dovrebbe avere nessuna difficoltà a soddisfare nuovi clienti e nuove esigenze, può essere una opportunità economica di grande sviluppo.
Ne abbiamo parlato recentemente con Donato Turba, noto macellaio e oggi anche ristoratore in quel di Melzo in provincia di Milano e dirigente di settore per
Confcommercio, una competenza certa, al convegno Meat Experience tenutesi a MalpensaFiere nel mese di aprile.
Può essere un’idea da sviluppare, i due settori si osservano da molto tempo, non poche macellerie hanno sviluppato angoli di somministrazione, così come molte pescherie, segno che i bisogni della ristorazione sono già esperienze vissute e collaudate.
La rivista iMEAT, direttore Luca Codato, con una lunga storia ed esperienza nel mondo delle carni, cercherà di cogliere e far cogliere questa opportunità di collaborazione tra ristoratori e macellai.

A Salerno, una bottega che dagli anni novanta alimenta il culto della carne di altissima qualità e una famiglia che con passione trasmette cultura del buon cibo
Ogni parola che Alberto De Martino pronuncia trasuda passione per il proprio
lavoro. Si percepiscono quella genuinità di pensiero che in un’attività come la macelleria si traduce in professionalità meticolosa e competenza, la capacità di tra-
smettere il valore del prodotto e la progettazione accurata che sono alla base dell’attività e ne determinano il successo.
“La cosa più importante – afferma De Martino – è la qualità della carne. Il nostro lavoro è fondato innanzitutto su quello e sulla capacità di preservare questo valore selezionando, trasformando e aggiornando le nostre scelte e il nostro modo di lavorare per sod-

disfare le attese della clientela che, negli anni, ha cambiato il proprio modo di comprare, cucinare, gustare quel prodotto così delicato e importante che è la carne”. È dunque con sensibilità e capacità di evolversi che Alberto De Martino e la sua famiglia gestiscono la loro attività di macelleria, oltre che con evidente conoscenza del mestiere. Doti che da domani saranno certamente anche le linee guida per suo figlio Raffaele che già oggi lo affianca con impegno. Un team ben affiatato, sei dipendenti fissi e altri che si alternano all’occorrenza, un negozio di soli 60 mq ma ben strutturato. “Ce
È importante aggiornare periodicamente le attrezzature e affidarsi a un fornitore di fiducia per avere efficienza migliore, risparmio energetico, e per mantenere la freschezza della carne sia in cella sia nel banco

Per noi Coldar è il top perché sanno interpretare le nostre esigenze con professionalità e disponibilità e metterle in pratica con allestimenti di grande qualità ed efficienza
tenso, ma il locale non è grande e per questo è importante poterlo attrezzare e allestire nel modo più efficiente e funzionale. Ogni 5-6 anni in media rinnovo l’arredamento e la tecnologia proprio per restare al passo coi tempi e con le esigenze del lavoro. Così come negli anni abbiamo adeguato il nostro assortimento di carni e oggi possiamo fornire ai clienti tagli pregiati provenienti da allevamenti diversi: Chianina, Rubia Gallega, Simmenthal, Sashi, Manzetta prussiana, Charra spagnola, Bue nero e Pezzata Rossa. Questo vuole la gente e se non ci aggiorniamo continuamente restiamo indietro. Sono le basi che ho insegnato a mio figlio: sempre restare al passo con i tempi e con l’evoluzione del pensiero e delle abitudini della gente. Mantenendo però altissima sempre la qualità del lavoro e del prodotto”.
que un elemento importante per Demar Carni e, infatti, per quanto riguarda l’allestimento del negozio, l’ultimo aggiornamento risale a pochissimo tempo fa, lo scorso mese di giugno l’inaugurazione. “Da molti anni – spiega De Martino – ci affidiamo a Coldar Frigoriferi. Loro sono il top per noi perché sono in grado di interpretare le nostre esigenze con grande professionalità, disponibilità e soprattutto con strumenti di grande valore: la qualità del loro acciaio è spettacolare, la tecnologia precisa e moderna. Siamo davvero soddisfatti perché riescono a realizzare su misura le nostre aspettative con grande serietà”.
merci e un ottimo risparmio energetico.
ne vorrebbe così di spazio – dice Alberto De Martino – almeno il doppio perché lavoriamo molto e abbiamo un giro di attività in-
Carni particolari, dunque, e l’arte della frollatura che, dichiara De Martino “Oggi è una moda che sta spopolando, e allora ci siamo adeguati, anche con le attrezzature idonee”.
L’aggiornamento continuo è dun-

Con un negozio di dimensioni contenute una delle esigenze principali era la gestione intelligente degli spazi. Demar Carni disponeva già di un banco Coldar con vasca da 80 cm e oggi l’azienda ha realizzato su misura il nuovo banco CUBE My Meat System con vasca da 98 cm. Per aumentare ancor più l’esposizione refrigerata, in affiancamento al capiente banco frigo, è stata realizzata la torre refrigerata bifacciale chiusa entrambi i lati con robuste porte in vetrocamera: Coldar ELON T 3R. Quest’ ultima esclusiva vetrina refrigerata, grazie a 3 ripiani regolabili in altezza, consente una brillante esposizione multipiano, la conservazione ottimale delle
Un nuovo arredamento accuratamente studiato in ogni spazio e l’ottimizzazione delle risorse hanno fatto la differenza per il rinnovo della macelleria Demar Carni. “È molto importante per noi aggiornare periodicamente le attrezzature affidandoci a un fornitore di fiducia – afferma Alberto De Martino – per avere efficienza migliore, soprattutto risparmio energetico, e per mantenere la freschezza della carne sia in cella sia nel banco. È un requisito fondamentale con un prodotto delicato come il nostro. Il ricambio della merce è continuo, perché abbiamo una clientela ampia, ma adesso posso lasciare la carne nel banco anche la notte, con un notevole risparmio di tempo e di energie”.
Carni di qualità, dunque, e un assortimento completato da piccola gastronomia e prodotti di eccellenza, perché “la gente non cucina più, non ha tempo, e dobbiamo aiutarli fornendo anche pronto cuoci e piatti pronti, anche se il nostro punto di forza resta la selezione e i tagli” afferma Alberto De Martino che conclude sorridendo: “Spendiamo tanto per avere un negozio all’altezza dell’attività, ma l’importante è che l’investimento sia soddisfacente. Noi siamo molto soddisfatti”.



I vantaggi di confezionare la carne fresca e di qualità in pack skin: una soluzione perfetta per la vendita al dettaglio di prodotti di alto valore

Giuseppe L. Pastori - Tecnologo Alimentare
La figura del macellaio dei tempi odierni si è evoluta notevolmente rispetto a quella tradizionale. Un tempo, infatti, ci si limitava a macellare gli animali e a vendere le varie parti della carne. Oggi invece i moderni macellai sono professionisti altamente qualificati e specializzati, in grado di offrire una vasta gamma di servizi e prodotti di alta qualità che vanno ben oltre la semplice vendita di carne. Rispetto alla grande distribuzione organizzata (GDO), uno dei principali vantaggi del macellaio che esercita in negozio è la sua capacità di offrire al consumatore soluzioni per trattare in modo adeguato la carne, grazie alla sua conoscenza approfondita del settore: non è semplicemente un operatore che, pur conoscendo l’anatomia dell’animale, si limita a porzionare le parti anatomiche che gli arrivano già confezionate. I macellai professionisti sono in grado di consigliare i clienti sulla scelta dei tagli di carne più adatti alle loro esigenze, fornendo suggerimenti sui metodi di cottura, di conservazione e sugli abbinamenti culinari. Questo tipo di consulenza personalizzata è molto apprezzata dai clienti, in particolare da coloro che cercano prodotti di alta qualità e un servizio più specializzato.
Inoltre, i macellai di oggi – definiamoli pure 2.0 per differenziarli da quelli di bottega del passato – si distinguono per la loro attenzione alla provenienza della carne e alla sostenibilità ambientale. Molti di loro selezionano con cura for-
nitori locali e produttori che rispettano elevati standard di benessere animale e pratiche agricole sostenibili, offrendo così ai clienti la possibilità di fare scelte consapevoli e responsabili. Inoltre, i moderni macellai spesso offrono anche una vasta gamma di preparati di carne pronti da cuocere come hamburger (di varie formulazioni), spiedini, carni marinate e altri elaborati di carne, spesso associati alla vendita di altri prodotti gastronomici e specialità artigianali come salumi, formaggi, condimenti e piatti pronti. Si crea così un'esperienza di shopping culinario più completa e coinvolgente. E ancora, coloro che sono più attenti alla sperimentazione, possono proporre carni stagionate bovine ovvero frollate per tempi superiori alle due settimane (che è il tempo medio per rendere la carne bovina pronta al consumo dopo la macellazione), fatte maturare in appositi stagionatori che possono fare anche bella mostra di sé in negozio; oppure possono offrire direttamente le loro specialità abbinandole alla ristorazione connessa al negozio o promuovere eventi e degustazioni per coinvolgere la comunità locale.
si sta facendo strada ultimamente anche un servizio orientato al packaging, vale a dire il confezionamento in pack skin. Tale tecnologia permette di consumare la carne fresca anche a distanza di più giorni, mantenendo intatte le caratteristiche proprie di qualità organolettiche e sensoriali e senza la necessità di doverla
Uno dei principali vantaggi del macellaio è la sua capacità di offrire al consumatore soluzioni per trattare in modo adeguato la carne, grazie alla sua conoscenza approfondita del settore
Tra queste diverse tendenze del mercato, che permettono ai moderni macellai di affermarsi come professionisti altamente specializzati,

Tra le diverse tendenze del mercato, che permettono ai macellai di affermarsi come professionisti altamente specializzati, si sta facendo strada anche un servizio orientato al packaging, vale a dire il confezionamento in pack skin
congelare se non viene consumata subito. Rispetto al passato e alla grande distribuzione organizzata, i moderni macellai si distinguono così non solo per la loro passione per la carne di qualità, la sostenibilità e l'innovazione, ma anche perché sono in grado offrire ai propri clienti un valore aggiunto e un servizio superiore che va ben oltre la semplice vendita del prodotto.
LA CARNE FRESCA IN MODO ADEGUATO L’offerta che si può trovare dal macellaio comprende sia la carne rossa costituita principalmente da manzo, maiale e agnello, sia quella bianca degli avicoli (pollo e tacchino) e della cunicoltura (coniglio). Le macellerie più specializzate possono proporre anche preparati di carne e carne stagionata (ottenuta cioè facendola maturare in appositi stagionatori, oltre il tempo di frollatura minimo, per 30, 60 o più giorni).
Quando si acquista della carne e la si porta a casa, il problema principale è legato al trasporto e alla durata di conservazione prima del consumo, a meno che non la si acquisti in grandi quantità per fare scorta e si provveda a congelarla in fettine o porzioni nei propri apparecchi domestici.

In generale però la corretta conservazione della carne fresca, dei preparati di carne e della carne stagionata che ci facciamo porzionare dal macellaio, è determinata principalmente da tre fattori: la temperatura di conservazione, lo stato igienico dell'alimento e il metodo di confezionamento.
Anche se ci focalizziamo in questo articolo solo sulle diverse modalità di packaging (esistono diversi concetti di imballaggio), tutti e tre i fattori sono fondamentali per prolungare la durata di conservazione e preservare la qualità della carne fresca. Un adeguato confezionamento, oltre a prolungare efficacemente la durata di conservazione, può contribuire a ridurre gli sprechi alimentari. L'imballaggio non deve modificare la qualità dell'alimento: ecco perché è importante effettuare un’accurata ispezione
Un adeguato confezionamento, oltre a prolungare efficacemente la durata di conservazione, può contribuire a ridurre gli sprechi alimentari

della sua qualità prima dell'imballaggio. È necessario anche operare nelle migliori condizioni igieniche, far attenzione agli altri ingredienti e alla condizione delle macchine, pulire in modo adeguato la superficie quando si prepara una costata o una bistecca da una lombata stagionata. Tuttavia, un imballaggio corretto può prolungare la durata di conservazione di questa categoria di alimenti evitando la crescita di microrganismi (che sono presenti sulle superfici delle carni) e l'inquinamento esterno, l'ossidazione e la decomposizione della carne, la perdita di umidità, ecc. , garantendo così la qualità organolettica del prodotto.
Un adeguato confezionamento della carne fresca può migliorare l'efficienza del trasporto dal negozio a casa, consentendo di riporla nel frigorifero in attesa di essere consumata senza toglierla dal suo involucro, evitando così il rischio di contaminazioni accidentali.
Un imballaggio adeguato può anche incentivare le vendite. Scegliere i materiali e i tipi di imballaggio in base agli interessi dei consumatori non solo può attrarre i clienti ma anche migliorare il valore aggiunto e la competitività dei prodotti. Anche nel caso della vendita al dettaglio, l’aspetto del marketing può costituire un plus interessante, specie se si ha la possibilità di comunicare informazioni sotto forma di QR code da inquadrare con lo smartphone. Considerando poi la tendenza verso una maggiore sostenibilità degli imballaggi e un livello di maggiore consapevolezza riguardo i temi ambientali, che derivano dalle discussioni sulla riduzione degli imballaggi di plastica, sono disponibili un’ampia gamma di soluzioni, che vanno da vaschette preformate a confezioni flessibili anche in carta/cartone accoppiati a pellicole che riducono al minimo l'impiego di plastica. Questi tipi di packaging possono essere lavorati su macchine a campana, termoformatrici o termosaldatrici, per creare confezioni sottovuoto, sottovuoto skin o in atmosfera modificata, il cui acquisto si può valutare per le diverse esigenze.

TIPOLOGIE DI CONFEZIONAMENTO
DELLA CARNE FRESCA
Uno dei materiali più comunemente utilizzati dai macellai per avvolgere la carne fresca (bistecche, macinato, parti porzionate, ecc,) è la carta politenata. Questa svolge la funzione di barriera tra prodotto e ambiente esterno durante il trasporto dal negozio a casa, garantendo un'adeguata igiene. Tuttavia la carne conservata nella carta non impedisce che si formi essudato e dovrebbe essere consumata il prima possibile o al massimo entro 1-2 giorni dall’acquisto, sempre che sia mantenuta alla temperatura adeguata e non siano presenti segni di alterazione.
Però quando parliamo di metodi di confezionamento per preservare la qualità della carne fresca in funzione della sua durata e conservabilità ci riferiamo ad altre metodologie, come ad esempio: l’avvolgimento di vassoi con film estensibile, il confezionamento sottovuoto (compreso quello con materiale termoretraibile), il confezionamento sottovuoto skin e quello in atmosfera modificata MAP. Ciascuna soluzione d’imballaggio presenta vantaggi diversi e offre una differente durata di conservazione: la scelta dipende dal tipo di carne (fresca, stagionata, con osso), dalla gestione del trasporto e dalla conservazione in frigorifero, ma anche dall’offerta di servizio per carni di qualità premium perché se ne riduca lo spreco, compatibilmente con gli aspetti di sostenibilità alimentare. Senza dimenticare che il macellaio professionista dovrebbe fare un investimento da ammortizzare in tempi congrui e soprattutto deve essere in grado di gestire la tecnologia. A parte l’acquisto dei materiali d’imballaggio, i sistemi più semplici richiedono nessuno o minimi investimenti, quelli più tecnici hanno bisogno di macchine adatte allo scopo: non tutte però sono alla portata dei macellai se non si fanno grandi numeri o serve una capacità tecnica nella gestione che le rende poco pratiche. Ecco una panoramica dei sistemi di imballaggio che possono essere impiegati per confezionare la carne fresca.
Il metodo di avvolgimento con film estensibile può essere adatto a macinato o bistecche o piccoli parti intere
1. AVVOLGIMENTO VASSOIO
CON FILM ESTENSIBILE
Il metodo di avvolgimento con film estensibile utilizza un vassoio in schiuma che contiene la carne e un tampone assorbente, avvolto con una pellicola di plastica trasparente permeabile all'atmosfera. Le caratteristiche di permeabilità del film consentono all’ossigeno presente nell’aria di entrare in contatto con la carne, mantenendone il colore rosso attraente per i consumatori. È un tipo di imballaggio molto economico, sia nei materiali utilizzati (vassoi in schiuma e film estensibili), che nell’avvolgitrice che può essere manuale. Lo svantaggio è che la durata di conservazione della carne è molto
prevede l’impiego di un vassoio di plastica rigida (o a base di fibre di cellulosa rigide) che contiene il prodotto a base di carne, un tampone assorbente per raccogliere il siero dell'alimento e la sigillatura con una pellicola di plastica ad alta barriera. Possono essere impiegate macchine termosigillatrici (se il vassoio è già formato) o termoformatrici (se il vassoio deve essere formato da un laminato), che utilizzano una miscela di gas purificati (come ossigeno, anidride carbonica, azoto o un gas inerte) per sostituire l’aria all’interno della confezione. Per la carne fresca si usa spesso una miscela di ossigeno (60/70%) e anidride carbonica (20/30%), dove la CO2 ha un effetto batteriostatico e l’ossigeno contribuisce a mantenere vivo il colore naturale della carne, che i consumatori associano a freschezza e qualità. Tuttavia le condizioni all’interno della confezione non rimangono in equilibrio perché i due gas interagiscono in modo diverso con la carne e anche a basse temperature la durabilità non va oltre i 7-8 giorni: trascorso questo tempo sopraggiungono modifiche di colore, consistenza e gusto. Le macchine non sono tanto ingombranti (a parte la termoformatrice che ha bisogno di una sezione con stampo per formare la vaschetta ad alta temperatura), ma il problema può essere la gestione dei gas (generalmente stoccati in bombole a rendere o in serbatoi) che richiede un minimo di conoscenza tecnica e ne limita l’impiego a laboratori di una certa dimensione e produttività.

breve, all’incirca 3-5 giorni a bassa temperatura, perché l'alimento è continuamente esposto all’ossigeno, quindi soggetto all’ossidazione delle proteine e dei grassi. Questo sistema può essere adatto a macinato o bistecche o piccoli parti intere.
2. CONFEZIONAMENTO IN ATMOSFERA MODIFICATA MAP
Il confezionamento in atmosfera modificata
Il confezionamento in atmosfera modificata richiede un minimo di conoscenza tecnica e ne limita l’impiego a laboratori di una certa dimensione e produttività
3. CONFEZIONAMENTO SOTTOVUOTO
Il confezionamento sottovuoto è una tecnica che viene già praticata da moltissimi anni sui tagli anatomici interi per favorire la frollatura (anche nota come wet aging cioè frollatura ad umido, per distinguerla dalla dry aging che si fa in una cella a ventilazione controllata). Per questo è poco praticata per il dettaglio al con-

sumatore finale mentre viene impiegata per la vendita di grossi pezzi porzionati destinati alla ristorazione o a ulteriore sezionamento. La confezione sottovuoto si presta anche ad essere congelata, perché l’involucro rimane perfettamente aderente impedendo bruciature da freddo. Utilizzata per la carne fresca ne prolunga la durata di conservazione. I tagli di carne sono inseriti in buste o sacchetti di plastica preconfezionati (ideali per le macchine confezionatrici sottovuoto a campana), realizzati con polimeri che forniscono una forte barriera di protezione contro abrasione, migrazione dell’umidità e permeabilità ai gas. La macchina rimuove completamente l’aria e sigilla la confezione impedendone l’ingresso. Poiché la busta può presentare delle grinze che si riempiono occasionalmente di siero, generalmente dopo la sigillatura le confezioni vengono fatte passare in una vasca di immersione in acqua calda che favorisce la termoretrazione dell’involucro, facendole restringere attorno alla carne e migliorando la presentazione (ciò non impedisce che si formi lo stesso un po’ di essudato perché l’involucro è flessibile e il peso della carne sul ripiano d’appoggio favorisce la fuoriuscita di siero). Occorre dire che il processo di confezionamento sottovuoto e la termoretrazione
La confezione sottovuoto si presta anche ad essere congelata, perché l’involucro rimane perfettamente aderente impedendo bruciature da freddo
sono due operazioni indipendenti, che necessitano quindi di due distinte apparecchiature. Il difetto della carne fresca sottovuoto è che a causa dell’assenza di ossigeno la carne tende a presentarsi più violacea, perciò serve avvisare i clienti – che non comprendono la variazione di colore – che l'alimento va fatto ossigenare fuori dalla confezione per 5-10 minuti, il tempo che riprenda il suo colore rosso bruno naturale. La carne fresca sottovuoto, mantenuta a temperature positive di frigorifero, può conservarsi all’incirca per 10-11 giorni dalla data di confezionamento.
4. CONFEZIONAMENTO SOTTOVUOTO SKIN
Il confezionamento sottovuoto skin è un’evoluzione tecnologica del sottovuoto che offre numerosi vantaggi rispetto a qualunque altro sistema. Offre allo stesso tempo un elevato livello di protezione dell’alimento e dona un aspetto attraente, perfetto per la vendita al dettaglio di prodotti di qualità premium e alto valore.
Questo tipo di confezione prevede che il film

superiore avvolga completamente e in modo strettamente aderente la carne fresca, quasi a formare una seconda pelle senza grinze e pieghe, prima di sigillarsi su tutta la superficie libera su cui poggia la carne. La base può essere preformata a partire da un laminato plastico oppure utilizza un cartone accoppiato con una pellicola, molto più sostenibile e riciclabile dal momento che i materiali si separano facilmente. Poiché è fissata saldamente alla base del vassoio, la carne fresca mantiene la sua forma naturale senza scivolare (le confezioni possono essere mantenute anche in verticale). Il vuoto nel packaging e l’assenza di pieghe che possono riempirsi di essudato, contribuiscono a prolungare la durata di conservazione della carne fresca fino a 18-21 giorni. Oltre alla carne morbida come il filetto o la polpa di roast beef, possono essere confezionati in skin anche altri tagli con superfici dure o parti taglienti, come le carni in osso (costate, T-bone, anche tagli di carne stagionata in genere, ecc.). L’aderenza del film offre infatti una protezione totale contro abrasioni e punture che in altri tipi di involucri possono portare a perforazione e perdita del vuoto. Per questo i film superiori hanno caratteristiche speciali, appositamente progettati per garantire le proprietà meccaniche e di flessibilità.
Anche se per una macelleria non è strettamente necessario offrire un servizio di confezionamento innovativo, è fuori ogni ombra di dubbio che chi tratta tagli di carne pregiata o con osso ma anche preparati di carne gourmet (perché, un hamburger da 200 e passa grammi, preparato con carni di eccellenza e d’origine certificata, non può essere un prodotto premium gourmet?), possa fornire un servizio complementare con un packaging attraente, che permette di conservare la carne un po’ più a lungo, garantendo un sapore eccezionale e riducendo lo spreco alimentare. Perché ci sono molti consumatori che di fronte alla durata di conservazione e alla presentazione della carne stessa durante una cena, si trovano nel dubbio di “comprare/non comprare” in un negozio anziché in un supermercato, ma anche sulla scelta di “consumare/non consumare” a casa.
Il confezionamento sottovuoto skin è un’evoluzione tecnologica del sottovuoto che offre numerosi vantaggi rispetto a qualunque altro sistema
Tra le opzioni di confezionamento della carne, il confezionamento sottovuoto skin è quello che offre le migliori condizioni per il consumatore e garantisce il valore aggiunto dell'alimento venduto dal macellaio. Non ha bisogno di assorbenti per ridurre la presenza di siero (perché questa sostanza non si forma), né di attrezzature particolari. Non necessita neanche di un magazzino di stoccaggio dei gas impiegando il processo MAP che modifica la composizione dell’aria interna alla confezione.
Nel confezionamento sottovuoto skin l’aria attorno al prodotto viene eliminata, impeden-
do così che l’ossigeno favorisca l’ossidazione e la crescita microbica. L’adesione del film superiore al prodotto e alla superficie libera del supporto di base è perfetta, non lascia spazi e pieghe che si possono riempire di siero e provocare un rammollimento della pellicola e la diffusione di siero sulla superficie della carne (con conseguente diffusione di microrganismi presenti). Riduce inoltre il rischio di danni fisici come la puntura o la perforazione del materiale che determinano la perdita di vuoto. Prolunga quindi la vita commerciale e la durata di conservazione. Anche in termini di sostenibilità l’impiego delle plastiche può ridursi di molto qualora si opti per una base di cartone (al posto di un vassoio di plastica) che può essere riciclata al 100%, senza sacrificare la qualità del prodotto. Il cartone inoltre può essere personalizzato con stampe, etichette interattive e QR Code che raccontano la storia dell’origine delle carni, il dettaglio del percorso lungo tutta la filiera di produzione, la logistica, gli ingredienti, le modalità consigliate di consumo, insieme alle informazioni sulla propria bottega e sulle politiche attuate per garantire la qualità del servizio offerto. Oggi che quasi tutti utilizzano lo smartphone anche per interagire con chi produce o per avere istruzioni di cucina, con modalità di cottura e ricette dettagliate, poter veicolare un messaggio positivo della propria attività contribuisce a fidelizzare il cliente. Per promuovere il confezionamento skin e soddisfare le richieste dei consumatori più informati ed esigenti, occorre che il professionista si impegni nel fare alcune azioni, tra queste escogitare modalità per illuminare la sezione di vendita del confezionato skin, offrire un facile accesso, informare con apposita cartellonistica (anche con slogan di lettura immediata) sulla qualità del servizio e sulle modalità di gestione. L’unica accortezza, che va incontro a chi è meno preparato, è quella di avvisare l'acquirente che, poiché in assenza di ossigeno la carne può apparire un po’ più scura e tendente al violaceo (che molti percepiscono in modo non positivo), è necessario lasciarla ossigenare all’aria per qualche minuto dopo l’apertura perché riacquisti il suo caratteristico colore naturale rosso bruno: è questo il parametro di valutazione da tenere in considerazione, cioè la carne dopo l’apertura.
Scegliere i materiali e i tipi di imballaggio in base agli interessi dei consumatori non solo può attrarre i clienti ma anche migliorare il valore aggiunto e la competitività dei prodotti
poco, mentre quelle che usano una base da preformare a partire da una bobina di laminato devono essere dotate della stazione di formatura. Sono facili da usare e molto efficienti. Tra le aziende italiane che si possono contattare figurano ItalianPack, Fabbri Group, Ilpra e G. Mondini (che produce macchine di una certa taglia più adatte a un laboratorio che a un negozio), ma tutti possono personalizzare le richieste.
La tecnica offre diversi vantaggi, non ultimo quello della conservazione che può essere prolungata di parecchi giorni (dalla data di confezionamento). La tecnica del sottovuoto skin è stata sviluppata proprio con l’intento di commercializzare piccole porzioni di carne fresca,
macinate o preparati di carne top per qualità, che potrebbero essere acquistati anche nei negozi al dettaglio.
In diversi studi sui consumatori è emerso che l’acquisto di carni confezionate in assenza di ossigeno viene preferito per la tenerezza, la succosità e il sapore che ha questo alimento trattato. Molti si dicono anche disposti ad acquistare carne confezionata in skin a un prezzo più alto. Non è quindi affatto un’eresia per il macellaio promuovere questa forma di confezionamento della carne di qualità, considerando la potenziale maggiore stabilità e conservabilità delle carni, se queste non vengono consumate subito dopo l’acquisto. Nel caso del confezionamento skin bisogna però – anche dal macellaio – investire nell’educare il consumatore, informandolo circa il naturale recupero del colore ottimale solo al momento dell’apertura delle confezioni.

Monitoraggio etichettatura facoltativa carni bovine
Il Ministero dell'Agricoltura, della Sovranità Alimentare e delle Foreste ha pubblicato il "Rapporto monitoraggio etichettatura facoltativa carni bovine - anno 2023", un documento alla sua 21a edizione, che presenta gli esiti delle verifiche condotte in Italia per assicurare la trasparenza del sistema di etichettatura delle carni bovine. Il documento ha l'obiettivo di tutelare gli interessi dei consumatori e, al tempo stesso, di valorizzare le produzioni nazionali di qualità.
Il rapporto ripercorre le ragioni e le normative alla base del programma di etichettatura delle carni bovine e ricorda che i controlli ufficiali in materia sono in carico al Ministero che opera attraverso l'Ispettorato centrale della tutela della qualità e della repressione frodi dei prodotti agroalimentari (Icqrf) e le Regioni e Province autonome.
Organismi Terzi accreditati si occupano della supervisione sulle diverse attività.
Nella seconda parte del Rapporto vengono riportati, in tabelle, grafici e immagini, informazioni circa il numero degli organismi di controllo, la loro dislocazione sul territorio nazionale e le informazioni facoltative incluse nei diversi disciplinari.
L'imballaggio sottovuoto skin utilizza materiali plastici all'avanguardia appositamente progettati per creare una confezione più attraente e sigillata in modo affidabile.
Le macchine per il confezionamento skin che impiegano vassoi o cartoni preformati sono relativamente semplici e occupano poco spazio. Le più piccole possono costare relativamente
Tra le informazioni che accompagnano le carni, anche quelle che riguardano le tecniche di allevamento con particolare riguardo al benessere animale; l'esame dei dati inerenti ai controlli effettuati e altri numerosi dati e analisi di dettaglio, compreso una analisi dei costi del sistema di etichettatura delle carni bovine che, complessivamente, valgono lo 0,07% del fatturato del settore.
Conclude il rapporto un'analisi delle prospettive future.
Il rapporto ha il merito di fare luce su un'attività complessa e con un rilevante impatto per tutto il settore produttivo delle carni bovine e per i consumatori che richiedono una comunicazione trasparente riguardo agli alimenti sul mercato.
Che il consumo di carne sia legato agli aspetti evolutivi del genere homo è, senza dubbio alcuno, un fatto ineluttabile, nel letterale senso del termine e con buona pace dei “no carne” ad ogni costo. Appare quindi chiaro che di pari passo alla crescente necessità dell’impiego di carne nella dieta, si siano sviluppate le tecniche di conservazione.
AI GIORNI NOSTRI, NON SOLO MODA
Nel corso del tempo e ancora oggi i metodi di conservazione quali il freddo, il sale e la loro combinazione erano e restano i cardini per la salvaguardia della nobile materia prima.
Dry Aging. Letteralmente significa invecchiamento a secco. Io preferisco definire il processo Frollatura che, invertendo l’ordi-
ne di traduzione, significa Maturation ossia Maturazione. Certo, in alcuni casi è solo un inseguire la moda come per l’esponenziale e demenziale consumo di simil-sushi, bisogna però fare delle nette distinzioni tra frollatura domenicale e criteri tecnologici atti a salvaguardare la qualità del prodotto e la salute del consumatore.
SE NON C’È ACQUA
NON C’È VITA
Il processo di frollatura, se applicato a regola d’arte, provvede a una eliminazione progressiva dell’acqua libera naturalmente presente. Sottraendo di fatto terreno fertile alla proliferazione di agenti patogeni ovviamente indesiderati. Per l’appunto: “se non c’è acqua non c’è vita”.
Sotto l’aspetto puramente biochimico poi, un percorso ben equilibrato di frollatura, per tempistica, grado igrometrico e temperatura,

favorisce la progressiva demolizione dei tessuti connettivi e smantella le catene complesse delle fibre muscolari. Il risultato è una maggiore digeribilità, la comparsa di generosi fattori gusto olfattivi e una più spiccata attitu-
dine alle molteplici tipologie di cottura, siano esse lente o rapide. 5 milioni di anni fa l’umanità imparava ad alimentarsi con la carne, oggi TECNOLOGIE ALIMENTARI e DRY AGER ® hanno solo reso questa necessità eccellente






ECOD SRL Unipersonale
Sede Legale: V.le Rimembranze 6 20020 Lainate MI
Redazione - Abbonamenti - Pubblicità Via Don Riva 38 - 20028 San Vittore Olona MI Tel. 0331 518056
abbonamenti@ecod.it www.ecod.it - www.imeat.it
Autorizzazione alla pubblicazione Tribunale di Milano n. 379 del 27/11/2013
Poste italiane spa - sped. in A. P. - 70% - DCB Varese
Direttore Responsabile
Luca Codato - codato@ecod.it
Redazione
Marina Caccialanza - redazione@ecod.it
Hanno collaborato a questo numero
Angela Mucciolo, Claudio Mucciolo, Giuseppe L. Pastori, Matteo Scibilia, Francesca Tagliabue
Grafica e impaginazione
Sabrina Zampini - grafica@ecod.it
Pubblicità
Marinella Puggia - marketing.giornale@imeat.it
Stampa Eurgraf sas
Trattamento dati privacy@ecod.it
Il contenuto della rivista non può essere riprodotto, salvo espressa autorizzazione.
Gli autori sono responsabili delle opinioni espresse negli articoli e delle relative bibliografie.
inviare una e-mail a abbonamenti@ecod.it con tutti i dati per il corretto recapito della rivista
Le modalità di pagamento verranno comunicate a seguito del ricevimento della richiesta. L’abbonamento può essere sottoscritto in qualsiasi giorno dell’anno e vale per i 6 numeri successivi. L’abbonamento partirà a pagamento avvenuto.




